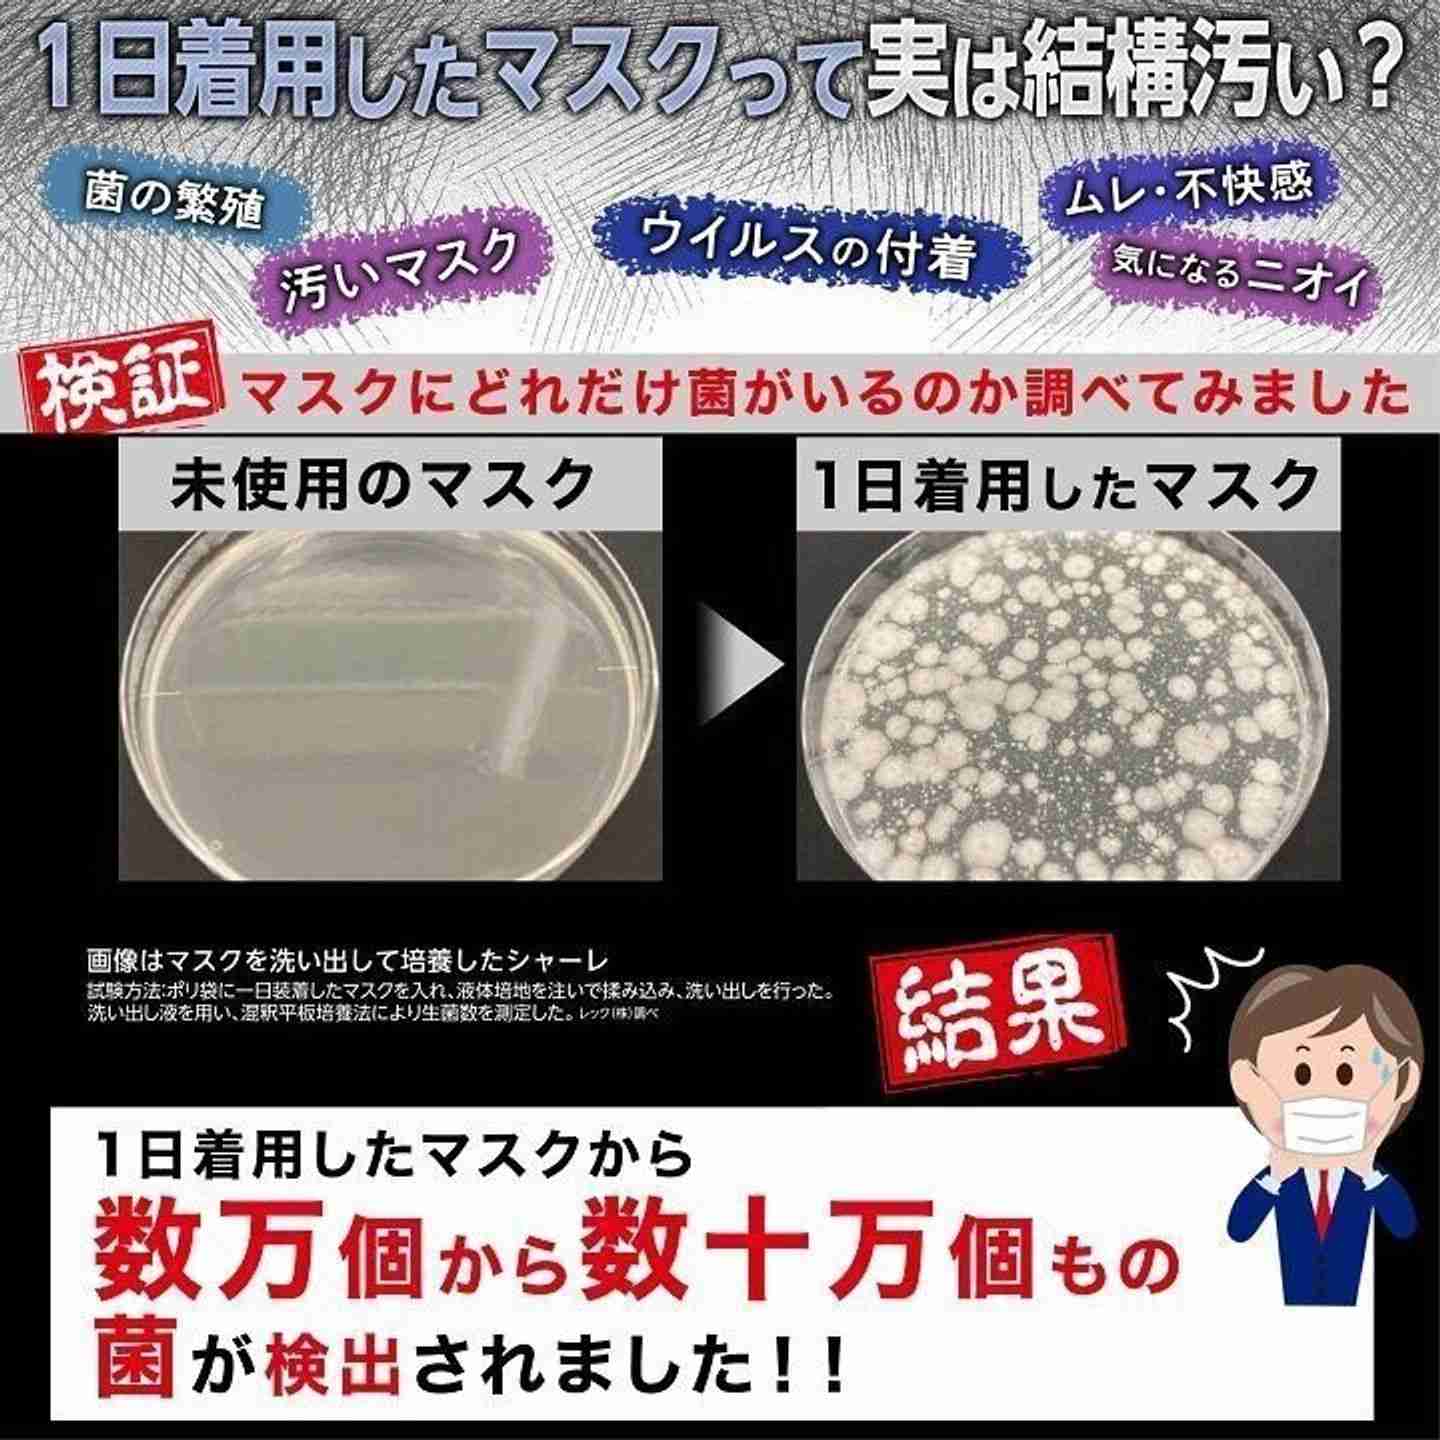
岸田首相「マスク、屋外不要」を強調　メッセージの出し方に苦悩

-
1. 匿名 2022/10/03(月) 21:44:28
加藤勝信厚生労働相は9月26日の記者会見で「(従来の発信が)分かりにくいとご指摘いただいたが、端的に言うと、屋外では基本的にマスクをする必要はないということだ」と言及。海外に比べ自然感染による免疫を獲得している人の割合が少ない日本では、「完全ノーマスク」に踏み切るのはリスクが高いというのが専門家の大半の意見だが、厚労省幹部は「1人で外を歩く際にも着けているのはやりすぎだ。夏だけでなく、秋も冬も一緒で、せめて『外では外す』を徹底したい」と話す。+470
-240
-
2. 匿名 2022/10/03(月) 21:45:02
おめぇは検討ばっかやないか+2283
-47
-
3. 匿名 2022/10/03(月) 21:45:26
火をつけたのはこいつ等だが
ここまで暴走したアホな国民にも呆れ果てる+1673
-122
-
4. Saint Bernard.田中 2022/10/03(月) 21:45:31
外で周りに誰も居ない&自転車移動とかまでマスクはさすがにね。私は外す。+2108
-55
-
5. 匿名 2022/10/03(月) 21:45:44
マスクしながら言う+1056
-22
-
6. 匿名 2022/10/03(月) 21:45:47
マスクにお金使うの嫌になる+1787
-32
-
7. 匿名 2022/10/03(月) 21:45:48
スーパーとかも、もうしなくていいって言え。+1194
-935
-
8. 匿名 2022/10/03(月) 21:45:48
不要なのは、+102
-10
-
9. 匿名 2022/10/03(月) 21:45:48
冬は暖かいからつけるかも+1115
-78
-
10. 匿名 2022/10/03(月) 21:46:00
外で外したい
散歩したりするときに息苦しさを感じる+1014
-37
-
11. 匿名 2022/10/03(月) 21:46:06
今さら屋外不要とか言われてもな
もうすぐ冬だしまた増えるよ+1188
-65
-
12. 匿名 2022/10/03(月) 21:46:06
今はもう管理が面倒だから外してない人が多いと思うよ+554
-23
-
13. 匿名 2022/10/03(月) 21:46:10
私はもう外ではマスク外したくない
見ず知らずの不特定多数に顔面晒すなんてことを今まで普通にやってたのがそもそもおかしかったんだよ+88
-226
-
14. 匿名 2022/10/03(月) 21:46:19
冬はマスクすると顔が暖かいからする+698
-37
-
15. 匿名 2022/10/03(月) 21:46:30
というか屋内もマスクいらない。+962
-359
-
16. 匿名 2022/10/03(月) 21:46:37
室内も不要
って言えば終わりじゃん
めんどくせー+1203
-180
-
17. 匿名 2022/10/03(月) 21:46:43
>>1
飛沫感染に敏感なマスク厨がうるさそう。この前も飲食店でくしゃみしたら(飛沫しないようにちゃんと抑えた)横のおじさんが「マスクしろよ」って本末転倒なこと言ってて呆れた。+17
-83
-
18. 匿名 2022/10/03(月) 21:46:49
おっさんの痰吐きやスーパーの袋の指舐めがまた始まるね。オエっ。+750
-46
-
19. 匿名 2022/10/03(月) 21:46:54
日本の内閣総理大臣は、辻元さんか、パククネにお願いします+5
-72
-
20. 匿名 2022/10/03(月) 21:47:01
マスク、壺議員不要で+32
-18
-
21. 匿名 2022/10/03(月) 21:47:04
>>7
スーパーは陽性者もいる可能性が高いからしてほしいわ+1208
-389
-
22. 匿名 2022/10/03(月) 21:47:16
冬になると寒いからマスクする人が増える。春は花粉症だし、来年の夏にやっとマスクなしの日々になりそう。+486
-9
-
23. 匿名 2022/10/03(月) 21:47:23
>厚労省幹部は「1人で外を歩く際にも着けているのはやりすぎだ。夏だけでなく、秋も冬も一緒で、せめて『外では外す』を徹底したい」
外したい人は外せばいいけど、外すことを政府が強要するのも変じゃない?
それぞれの事情でマスクし続けたい人はすればいいと思うけど、コロナ前そうだったし+682
-82
-
24. 匿名 2022/10/03(月) 21:47:29
政府の言うことは信用出来ないなあ。
私は感染したくないのでマスクはこれからも常時着用する。それで防げるなら安いモンだわ。
+367
-253
-
25. 匿名 2022/10/03(月) 21:47:37
マスク外すのはもう無理だよ+95
-94
-
26. 匿名 2022/10/03(月) 21:47:51
もう冬だし来年の春まではマスクするわ+304
-79
-
27. 匿名 2022/10/03(月) 21:48:06
>>1
んなことは知ってるし屋外でなんてしてない
次の問題は屋内でどうするかってこと
普通に考えて黙って一人で買い物するのにマスク要らんでしょう
私は海外のようにここだけはマスクしてねってエリア(たとえば医療機関と介護施設、ラッシュの交通機関等)を除外してあとは自由でいいと思ってる
+616
-43
-
28. 匿名 2022/10/03(月) 21:48:14
売国奴すぎてこいつの言うことなんも信用ならん+296
-6
-
29. 匿名 2022/10/03(月) 21:48:15
これから寒くなるっていうのに、なぜこのタイミングなのか+297
-22
-
30. 匿名 2022/10/03(月) 21:48:30
>>11
これからは風邪予防のためにつけるつもり+324
-37
-
31. 匿名 2022/10/03(月) 21:48:37
なんか面倒くせー+69
-6
-
32. 匿名 2022/10/03(月) 21:48:39
したい人はしたらいい、したくない人はしなくていいって国や政治家が言わないと日本国民はマスクの呪縛から解かれない。+471
-4
-
33. 匿名 2022/10/03(月) 21:48:44
言われなくても屋外ではとっくにつけてないけど+302
-24
-
34. 匿名 2022/10/03(月) 21:48:46
2メートル距離が取れてる場合は〜とか言ったのはどうなったん?
まぁ明らかに人少ない外では外してるけど。夏は暑くてやってられないよ+278
-3
-
35. 匿名 2022/10/03(月) 21:48:50
>>6
ほんとこれ!したくもないマスクになんでお金使って買ってるのか意味わからんくなる+615
-15
-
36. 匿名 2022/10/03(月) 21:48:55
今日公園で子供とノーマスクで遊んでたら
マスク警察じいさんにわざとらしく咳払いされた+222
-21
-
37. 匿名 2022/10/03(月) 21:49:07
8波まだかな。
不謹慎なのは承知してるけど、コロナ禍でありがたい事たくさんあった。
テレワークに今すぐ戻りたい。+24
-54
-
38. 匿名 2022/10/03(月) 21:49:26
今鼻水だらだらだから
私はつけるわ+57
-5
-
39. 匿名 2022/10/03(月) 21:49:33
屋内でも外してるよ
岸田に言われなくても体調により着けるか着けないかを自己判断する
着け過ぎたら体調悪化するわ+299
-49
-
40. 匿名 2022/10/03(月) 21:49:37
職場の人が風邪引いたって笑いながら出社してんだけど自分だけなのか凄い嫌だ。咳と喉がちょっとだし熱もないからって。コロナは?って聞いたらそんなのあったね位のノリだし周りもそう自分だけ気になるのがおかしいのか…+164
-43
-
41. 匿名 2022/10/03(月) 21:49:39
>>6
せめて可愛いの買うようにしてモチベ上げてる+79
-50
-
42. 匿名 2022/10/03(月) 21:49:52
冬はするよ鼻水だらだらだから+36
-10
-
43. 匿名 2022/10/03(月) 21:50:08
そんなにマスク外させたいんなら、テレビとかYouTubeとかいろんなところで宣伝しなよ。厚生労働省とかの名前で指針みたいなの出してくれたら、こちらも外す大義名分ができていいわ。+301
-10
-
44. 匿名 2022/10/03(月) 21:50:19
>>11
野外不要は夏始まる時点でもう言ってたけど
なかなか広報が仕事しないね+273
-1
-
45. 匿名 2022/10/03(月) 21:50:23
発熱してからの発症者も、濃厚接触者もまだ5日とか休まなきゃいけないんだし外せって風潮になるのはちょっと微妙(人のいない屋外なら良いけど混むとことか)
正直去年の夏と比べて、子供や親の感染が結構多くて仕事休む人も今年はほんと多かった。+241
-22
-
46. 匿名 2022/10/03(月) 21:50:24
日本、岸田不要
みたいに聞こえた+207
-5
-
47. 匿名 2022/10/03(月) 21:50:42
>>21
したいひとがすればいいじゃん+309
-75
-
48. 匿名 2022/10/03(月) 21:51:03
もうどう転んでも満場一致にはなりえないんだからハッキリ舵を切ろう。付けたいひとは付けるでいい、コロナ前、例えばインフルエンザ流行のときとかからそうじゃない。なんかあったとき責められたくないから国は及び腰なんだって印象しか自分は感じないよ。+263
-7
-
49. 匿名 2022/10/03(月) 21:51:19
それより旅行割と帰国時のワクチン3回と陰性証明縛りなんとかしてくれませんかね?+276
-10
-
50. 匿名 2022/10/03(月) 21:51:21
感染したくないからマスクするって言ってる人の中に本当は顔を隠したいからそれを免罪符にしてる人が多いんだろうな+256
-19
-
51. 匿名 2022/10/03(月) 21:51:25
>>3
暴走してるのもちょっと極端な人たちだけだと思うけどね
もうマスク自体いらないって人もそれなりにいるけど
従順な国民性って悪い方向に出ると本当にダメだねえ
まあ常時マスク付けてた方が会話する時とか口臭とかの面で
気を使わずに都合よかったりする面もあるけど
そろそろ強制はやめたいよね+315
-16
-
52. 匿名 2022/10/03(月) 21:51:33
お前はコロナになって回復したから怖いもの無しだろうけど+10
-9
-
53. 匿名 2022/10/03(月) 21:51:40
>>1
じゃあお前もマスク外して外歩けよ+14
-12
-
54. 匿名 2022/10/03(月) 21:51:48
>>6
年間にすると結構な金額になるよねぇ。
わたしは興和の三次元マスク30枚入箱をかってるけど約1ヶ月1箱1000円、年間12000円くらい。+278
-9
-
55. 匿名 2022/10/03(月) 21:51:57
>>6
みんな結構使ったよね
お金使うなら日本製を頑なに実行した+327
-3
-
56. 匿名 2022/10/03(月) 21:52:05
必死で着けさせてた以上に外すキャンペーンしないとなかなか外さないよ
特に子供たちはマスク依存症になってるから難しいと思う+187
-2
-
57. 匿名 2022/10/03(月) 21:52:18
時と場合によるし自分で考えてつけたり外したりしてるよ。
スーパーで泣き叫んで鼻水たらしてるような子供に限ってマスクしてないときや、くしゃみや咳を手で抑えずにしまくってる爺さんには、
マスクしてよとは思うけど+19
-7
-
58. 匿名 2022/10/03(月) 21:52:22
首相の言葉を聞かない国民。
これがもう答えだよ。
+32
-6
-
59. 匿名 2022/10/03(月) 21:52:22
>>13
付けてたい人はずっと付けてていいと思うよ
その必要の無い場面で他人に付けろ付けろと無理強いするのは間違ってるけど+186
-1
-
60. 匿名 2022/10/03(月) 21:52:28
そもそもマスクは自由です!
位言えないものか。
もうダメダメ政権。+191
-4
-
61. 匿名 2022/10/03(月) 21:52:34
責任取りたくないなら首相辞めましょうや。+23
-4
-
62. 匿名 2022/10/03(月) 21:52:38
>>1
基本的に外でも中でもノーマスクなんだけど、幼稚園の中だけはノーマスクハードル高い+41
-14
-
63. 匿名 2022/10/03(月) 21:52:43
まだコロナに感染してない人!🙋
わたしはたぶん感染してない!
+224
-11
-
64. 匿名 2022/10/03(月) 21:52:49
叩かれたくなければ、とりあえずマスクは必要、って言うしかない空気。
その空気を作ってる大半は感染予防よりただ顔を隠したい人たち。隠したいレベルの人の方が圧倒的に多いのに、いつまでもその人達の顔色伺っててバカみたい。+120
-15
-
65. 匿名 2022/10/03(月) 21:52:52
>>16
そのくらい言わないとたぶんみんな屋外でも外さなそうですよね。+227
-5
-
66. 匿名 2022/10/03(月) 21:53:13
なんかマスク外したくない
メイクめんどくさいし 顔さらしたくない
やっぱり習慣化しちゃったな+41
-51
-
67. 匿名 2022/10/03(月) 21:53:14
スーパー、コンビニ、ドラストでもマスク外してる。
誰かが変えなきゃ一生変わらないよ。+185
-69
-
68. 匿名 2022/10/03(月) 21:53:26
>>47
そうなったら陽性者もノーマスクでコンコンするようになるから嫌+124
-50
-
69. 匿名 2022/10/03(月) 21:53:27
>>1
岸田さんの使ってるダイヤモンド型マスクって韓国製のかな?+12
-7
-
70. 匿名 2022/10/03(月) 21:53:30
>>4
用事があってマスクしてて、そのままはずすの忘れて自転車に乗ってる時ある。+171
-2
-
71. 匿名 2022/10/03(月) 21:53:41
ひとりのときは無言だから多少人がいようとも外すんだけど、家族以外といったのときはつける羽目になる。
ただでさえ暑くて不快なのに、不織布の内側毛羽立ってるとくすぐったくてさらに不快でもう嫌。
安いマスク使ってるのが悪いんだけどさ。
金かけたくないのよ…布マスクも使ってるけど。+48
-3
-
72. 匿名 2022/10/03(月) 21:53:47
>>6
中国人ウイルスのせいでね。中国ごと消えて欲しい。+354
-10
-
73. 匿名 2022/10/03(月) 21:53:54
悪いことしてなくても監視カメラに取られたくないしマスク定着しそう+0
-3
-
74. 匿名 2022/10/03(月) 21:54:09
コロナ禍の前インフルが流行っててもマスクしてるのなんて一部の人だけだったもんなぁ
マスクして予防しなきゃ!みたいな意識がなかった
罹ったら罹った時みたいな+99
-4
-
75. 匿名 2022/10/03(月) 21:54:12
私はめっちゃ地味主婦だけどコロナ初期から基本マスクしてないわ+23
-20
-
76. 匿名 2022/10/03(月) 21:54:24
これでも安倍さんよりは仕事できる
日本の政治家が駄目すぎて韓国がうらやましいよ
不正したらちゃんと逮捕されている
安倍さんは逮捕されずに死んだ+5
-18
-
77. 匿名 2022/10/03(月) 21:54:24
どうせ最後は『各自治体に任せる』で丸投げにしそう
+61
-0
-
78. 匿名 2022/10/03(月) 21:54:28
>>4
周りに人がいる状態だと屋外ですらマスクする人本当に多いよね
全員がしたくてしてるとはとても思えない
日本人が人目気にする傾向あるとは知ってたけど、ここまでとは思わなかった+304
-15
-
79. 匿名 2022/10/03(月) 21:54:34
>>23
国民を思い通りにする癖ついてるんだよ
思い通りになってるしね実際+69
-2
-
80. 匿名 2022/10/03(月) 21:54:48
>>5
ホントそう言うところだよね。
結局は叩かれないように守りに入る。+183
-2
-
81. 匿名 2022/10/03(月) 21:54:49
>>9
私コロナ前から冬のマスクは防寒になるよキャンペーンを個人的に展開してたんだけどその頃はブス隠しだとバカにされてたなあ…+127
-5
-
82. 匿名 2022/10/03(月) 21:54:50
せめて4月以降はどちらもはずすようにしたらどうかな。
これからインフルエンザ流行るしとりあえず今年の冬はマスクあってもよいと思う。
+32
-10
-
83. 匿名 2022/10/03(月) 21:55:11
2類相当の扱いのままじゃ無理じゃない?+38
-2
-
84. 匿名 2022/10/03(月) 21:55:16
>>68
じゃああなたががっちり二重マスクつけたら?
自己防衛でいいと思うけど+69
-52
-
85. 匿名 2022/10/03(月) 21:55:50
屋外の公園とか人けのない閉店間際の小さなスーパーの出口でも、外してると超見られる
全員に振り返ってジロジロとw
顎にでもいいからマスクしてないとまだまだ冷たい視線浴びるよ…+50
-5
-
86. 匿名 2022/10/03(月) 21:55:57
田舎だからなのかノーマスクの人見ない😨
皆好きで付けてるの?+7
-9
-
87. 匿名 2022/10/03(月) 21:55:59
岸田は無能+54
-4
-
88. 匿名 2022/10/03(月) 21:56:16
>>4
その辺りは自力で考えればいいだけなのに、なんでできないんだろうね+34
-3
-
89. 匿名 2022/10/03(月) 21:56:45
>>78
家族に基礎疾患あるから外でもマスクしてます
それを人目を気にするからとはてめーの脳みそ虫か?虫なのか?+20
-64
-
90. 匿名 2022/10/03(月) 21:56:51
>>62
外で知り合いのママさんにあった時は、マスクなしで普通に会話してますか?+20
-7
-
91. 匿名 2022/10/03(月) 21:56:59
>>67
私もそう!
子供の手本になるように大人が率先して外していかないと日本の未来は大変なことになるよ。+112
-36
-
92. 匿名 2022/10/03(月) 21:57:01
>>86
そうだね
マスクファンなんだろう+5
-1
-
93. 匿名 2022/10/03(月) 21:57:07
インフルの同時流行警戒って、どさくさに紛れてインフルも2類並の扱いにしようとしてるように感じてしまう。
子供から大人までマスクとワクチンの強要。
インフルが流行ろうが、コロナが流行ろうがマスクはそれぞれ個人で判断する。
することもしないことも人に強要してはいけないでいいと思う。+59
-0
-
94. 匿名 2022/10/03(月) 21:57:21
>>74
してたけど必ず風邪ひいたの?って聞かれてた
予防ですって応えてたけど+38
-0
-
95. 匿名 2022/10/03(月) 21:57:31
>>75
出かけるときはするよね?+7
-9
-
96. 匿名 2022/10/03(月) 21:57:41
>>11
10/11から増える外国人観光客のために言ってるんだろうな
こいつ日本人のために動いた実績あるんかな?+288
-2
-
97. 匿名 2022/10/03(月) 21:57:42
>>88
マスクしないと変なのに絡まれる危険もある
マスクしろって殴られたとかしょっちゅうニュースでやってるし+17
-8
-
98. 匿名 2022/10/03(月) 21:57:58
>>21
レジの人対応しないとダメだしね+70
-23
-
99. 匿名 2022/10/03(月) 21:58:04
井戸端会議ばーさんはマスクをつけるべき+10
-1
-
100. 匿名 2022/10/03(月) 21:58:06
マスク外すことに反対してるのってブサイクしかいなさそう
この流れに乗ってマスクしてブサイク隠したところでブサイクなのはかわらないのにねぇ
賢い人は今の内に整形してる+50
-33
-
101. 匿名 2022/10/03(月) 21:58:10
>>29
もうはっきり言ってコロナなんて風邪って判断するほかないほど弱毒化してるからでしょ+114
-16
-
102. 匿名 2022/10/03(月) 21:58:17
>>79
馬鹿にされてるよね
実際馬鹿だけどね+27
-2
-
103. 匿名 2022/10/03(月) 21:58:18
>>74
東京の私の周囲の話だけどマスクの人結構いたわ
主に花粉症とかそんなん+15
-3
-
104. 匿名 2022/10/03(月) 21:58:24
日本人は自然免疫を獲得している人が少ないからって、、、
その理屈なら、若者や健康に問題ない人は積極的にマスクを外した方が、マスク社会終わるんじゃない?
ちなみにワクチンでは免疫獲得にならないって事ですよね?
高齢者以外はますますワクチンの意味ないですね。+111
-3
-
105. 匿名 2022/10/03(月) 21:58:37
>>23
スーパーとか行くと、マスク着用を強要されてる…
外すのを強要されるのも、着用を強要されるの、どっちもおかしい!!
屋外も室内も、着脱は自由であるべき。+61
-25
-
106. 匿名 2022/10/03(月) 21:58:54
>>101
横
死亡者が増えてるのは何だろね
+9
-24
-
107. 匿名 2022/10/03(月) 21:58:57
マスク苦しくて口呼吸なんだけど😫+28
-1
-
108. 匿名 2022/10/03(月) 21:59:04
>>100
え?整形したの?+23
-0
-
109. 匿名 2022/10/03(月) 21:59:24
>>34
「近くで会話をしない限り」の条件つきらしい+9
-0
-
110. 匿名 2022/10/03(月) 21:59:25
>>96
無いでしょ
無いから総理になれたのかもね🙄+102
-2
-
111. 匿名 2022/10/03(月) 21:59:31
>>21
どこにでも陽性者いるでしょ。陽性者がゼロになることは無いんだから怖い人だけしてれば?
そもそもマスクでウイルスは防げないし。+295
-49
-
112. 匿名 2022/10/03(月) 21:59:34
岸田さんて説得力ないし総理に向いていないと思う。
日本の為に何かいい事やってくれたっけ?+75
-1
-
113. 匿名 2022/10/03(月) 21:59:35
>>106
ふーんそうなんだ
もう誰も関心ないでしょ+13
-10
-
114. 匿名 2022/10/03(月) 21:59:45
>>103
東京に住んでたけど花粉症の季節はかなりつけてる人いた
花粉症なるべく吸わないように予防にもなるらしいね+16
-1
-
115. 匿名 2022/10/03(月) 21:59:53
結局店内ではマスクの着用が必要だからマスクの持ち歩きは必要だよね。
付けたりしまったりが面倒だから結局今後も付けたままになりそう。+24
-6
-
116. 匿名 2022/10/03(月) 22:00:00
>>89
家でもマスクしてるんですか?+37
-10
-
117. 匿名 2022/10/03(月) 22:00:05
私もう外では外してるわ
子供も外せばいいと思うよ
すれ違っても誰もジロジロ見ないよ+98
-6
-
118. 匿名 2022/10/03(月) 22:00:07
>>101
感染者数めっちゃ多いし、弱毒化はないと思う
単に我々人間が数千人感染とか死亡とかに慣れてきたってだけで、ウィルスは相変わらず元気だよ+14
-29
-
119. 匿名 2022/10/03(月) 22:00:16
>>4
人がいても外でははずしてるよ。
まだしてる人ばかりだけどね。+131
-14
-
120. 匿名 2022/10/03(月) 22:00:24
>>107
口臭くなるし、歯並び悪くなるし、ブスになるよー!!+48
-1
-
121. 匿名 2022/10/03(月) 22:00:29
もー大丈夫だって!
室内も不要って言ってーー
したい人だけ着用すればいい+120
-7
-
122. 匿名 2022/10/03(月) 22:00:44
>>2
あと誠に遺憾だね+163
-3
-
123. 匿名 2022/10/03(月) 22:00:47
>>3
Twitterとかヤフコメでも自分が見る限りではかなり脱マスクしたいの流れになって来てるけど、未だに「マスクはルール、マナー、ノーマスクは非常識」っていう刷り込みから抜け出せない人達もいるようだね・・・
Twitterではルールならお尻ぷりぷりダンス踊るってルールでも従うのかよ、そんなルール要らないって怒るだろって言ってる人いて確かにと思ったわ+225
-33
-
124. 匿名 2022/10/03(月) 22:00:55
>>2
この人は何をしたの?
強引の国葬だけ?
国のトップがこれだと恥ずかしい+166
-9
-
125. 匿名 2022/10/03(月) 22:01:07
>>10
別に外せばよくない?
+285
-3
-
126. 匿名 2022/10/03(月) 22:01:09
仕事が接客業だから仕事中はおそらく必ずマスクがまだ続くと思う。。百貨店勤務なので。。。だから私は屋外だけでもせめて外したい!本当に苦しい!呼吸が浅くなるしね。。。もう明日から屋外ははずす!!+57
-0
-
127. 匿名 2022/10/03(月) 22:01:14
>>10
外せばいいじゃん+230
-3
-
128. 匿名 2022/10/03(月) 22:01:27
スタジオ収録のテレビの芸能人は着けないでいいんかい!そんだけのウイルスってことやろ?はよ指定感染症外して+43
-0
-
129. 匿名 2022/10/03(月) 22:01:35
今は秋の花粉症あるのでマスクするし、冬は喉が乾燥するのでするし(めちゃめちゃ喉弱い)、春は春の花粉症でするし、夏は秋の花粉症が早いとやってくるからするし、結局通年してるわ。なんか私可哀想?と思うけど、花粉症はもっと症状重い人たちってたくさんいると思う。みんな結局つけてそう。+11
-2
-
130. 匿名 2022/10/03(月) 22:01:47
>>97
逆だよ!
ノーマスクに注意したばかりに殴られて亡くなった人もいたよ+5
-17
-
131. 匿名 2022/10/03(月) 22:01:50
>>10
なんではずさないか謎+233
-3
-
132. 匿名 2022/10/03(月) 22:01:59
私マスクを見えるように手に持って歩くようにしてるんであんまり警戒されてない
マナーとして室内に入るときはどうせつけるし
白黒つけるよりこうやってグレーでいけば全然衝突とかない+18
-1
-
133. 匿名 2022/10/03(月) 22:02:03
>>3
昨日外でマスク外して歩いてみたけどなんか見られてたような気がして同調圧力すごかった
9割はマスク付けて歩いてて、まだまだ時間かかるなこれは…と思ったよ
ちなみに地方都市+195
-19
-
134. 匿名 2022/10/03(月) 22:02:05
>>118
私の周りの感染者みんな軽症だわ
せいぜい一日熱出たくらい
さすがにもうコロナ終わった感漂ってる+60
-8
-
135. 匿名 2022/10/03(月) 22:02:08
>>122
注視もできる+28
-2
-
136. 匿名 2022/10/03(月) 22:02:13
もっとちゃんと周知して。
マスクが常識になった子供たちに、まずちゃんと説明して!+33
-0
-
137. 匿名 2022/10/03(月) 22:02:29
>>49
同感です!
3回打とうが4回打とうが、感染するんだから
関係ないと思う。
+142
-0
-
138. 匿名 2022/10/03(月) 22:02:30
>>1
もう今若い人でコロナが怖いからマスクしてる人ってあんまいないでしょ
皆顔を隠したいからしてる
その証拠にノーマスクなのはほぼオジサンで若い女性はほぼマスクしてる
+85
-13
-
139. 匿名 2022/10/03(月) 22:02:43
>>1
「原則」とか「基本的に」とか曖昧な表現使うと人によって解釈分かれるぞと思う+38
-0
-
140. 匿名 2022/10/03(月) 22:02:48
>>7
スーパー入るとマスク着用でアルコール消毒して入店しろって放送流れてるもんね。
あれでマスク無しはさすがに勇気いる、顔丸出しになるって事だし。
ああいう方法も控えていくべきなのかもね。+329
-28
-
141. 匿名 2022/10/03(月) 22:02:53
スーパー行ってマスクしてて外すの忘れてそのままつけてることよくあるわー。なんかつけたり外したりが面倒でつけっぱなしが多い。+9
-1
-
142. 匿名 2022/10/03(月) 22:02:58
付けたり外したりが面倒だからつけっぱなしにしてること多い
この前スーパーにマスク持ってくの忘れて家に戻ったんだけど、うっかりつけ忘れたとかあるから人混みとかお店に行く時はつけっぱなしにしてる+8
-1
-
143. 匿名 2022/10/03(月) 22:03:06
>>10
なぜ外さない??
そもそもコロナ禍始まって外ではマスクつけてないわ+164
-13
-
144. 匿名 2022/10/03(月) 22:03:06
>>130
逆ではないでしょ+13
-1
-
145. 匿名 2022/10/03(月) 22:03:27
>>21
それ言ったら結局キリがないじゃん
症状がある人だけにして欲しい+171
-23
-
146. 匿名 2022/10/03(月) 22:03:29
>>89
じゃあ大切な人を守るために家でこそマスクしないとですね+61
-8
-
147. 匿名 2022/10/03(月) 22:03:34
>>44
一応CMやってたよね
でもノーマスクは変な人くらい
アゴマスクはイキった陰キャとおっさんばかりだし
イメージがね+5
-24
-
148. 匿名 2022/10/03(月) 22:03:45
>>1
外すのは強要しないで欲しいな。
アレルギーとか、外のにおいが苦手(排気ガスや花屋、甘いお菓子のお店)でつけてる人もいる。
外したい人は外したらいいよ。室内はともかく、外ではコロナ前の状態に戻る感じ。+50
-7
-
149. 匿名 2022/10/03(月) 22:03:50
>>108
私はする必要がない美人なのよ
早くマスクを外してマスク美人のレッテルをはがしたくてね+37
-6
-
150. 匿名 2022/10/03(月) 22:03:53
>>133
アナタが敏感なのか私が鈍感なのか…
昨日一日横浜出歩いてて外では一回もマスクしなかったけれどそんなの感じなかったけれどなあ
それかアナタが美人だから見られてたのでは?
+106
-9
-
151. 匿名 2022/10/03(月) 22:03:54
>>9
インフル予防にも着ける+137
-14
-
152. 匿名 2022/10/03(月) 22:04:02
>>16
わたしはもう外してるよ。
息子は学生だけど、何年もマスクだから外すのに抵抗あるみたい。いっそ外していいって宣言してくれたらいいのに
若い子にはすごい影響与えてるよ。+165
-32
-
153. 匿名 2022/10/03(月) 22:04:03
>>国内でも「いつになったら外せるのか」との声が強まっている。
けっこう前から屋外ではマスク外しましょうって言われてない?みんな好きでマスクしてるんじゃないの?+9
-3
-
154. 匿名 2022/10/03(月) 22:04:10
>>10
外したい、じゃなくて外せばいいのになんで頑なに外さないのか理由を聞きたい+179
-5
-
155. 匿名 2022/10/03(月) 22:04:11
>>7
スーパーは必ず着用。
きったねぇジジババほんと多いから。+463
-120
-
156. 匿名 2022/10/03(月) 22:04:14
電車と病院は絶対外さない+10
-7
-
157. 匿名 2022/10/03(月) 22:04:26
>>67
コロナ怖く無いですか?+5
-45
-
158. 匿名 2022/10/03(月) 22:04:29
>>134
若い人が軽症なのは前からだし、弱毒化と関係ないと思うんだけど…+9
-10
-
159. 匿名 2022/10/03(月) 22:04:32
確かに、マスク外したくないって言ってる人は顔に自信ない人ばっかり+50
-8
-
160. 匿名 2022/10/03(月) 22:04:39
>>60
まー過去の総理がマスク配ったしね
いまさらマスクなんて要らなかったとか言ったら大騒ぎよねw
+6
-7
-
161. 匿名 2022/10/03(月) 22:04:50
>>148
外人向けのパフォーマンスだから外せって強要してるんだよ+14
-1
-
162. 匿名 2022/10/03(月) 22:04:51
屋内では付けて!人と話すときは付けて!ってなると、面倒だからつけたままになる。
もう一律で不要にすればいい。
必要な人は付けるから。+65
-0
-
163. 匿名 2022/10/03(月) 22:04:52
花粉終わったら外すね!
だから大体5月位かな。今はイネとブタクサだから。2月中旬位から杉で次に檜。真冬は花粉特にないけ顔ど寒いから着けておく。+8
-2
-
164. 匿名 2022/10/03(月) 22:05:14
変な日焼けするの嫌なんで夏から屋外はずっと外してるよ
でも屋内はまだつけるつもり
持病あったりする人へ思いやりの気持ちは持ちたいんで
+6
-10
-
165. 匿名 2022/10/03(月) 22:05:18
>>26
こういってる人は大体春になっても結局外さない(笑)+59
-5
-
166. 匿名 2022/10/03(月) 22:05:28
>>10
とりあえず家の周辺あたりから外してみては?始めはドキドキしてなんか悪いことしてる気分になるけどだんだ慣れるよ!+33
-2
-
167. 匿名 2022/10/03(月) 22:05:33
マスクしだしてから顎ニキビにずーーーっっと悩まされてるから本当に外したい。冬のインフル対策みたいに、したい人がしたらいいじゃん。
陽性の人は出勤とかできないのは変わらないんだから。インフルも出勤停止だし同じ対応でいいじゃんねー。+21
-0
-
168. 匿名 2022/10/03(月) 22:05:36
>>160
カビた布切れ…+7
-3
-
169. 匿名 2022/10/03(月) 22:05:39
真夏は屋外ではノーマスクの人そこそこいたけど、暑さが和らいだせいか屋外でマスクつける人また多くなった…
幼い子供達にいつまでマスクだらけの異様な世界を見せる気なのかとウンザリする。+54
-3
-
170. 匿名 2022/10/03(月) 22:05:45
どう見られようと気にしないアラフォー主婦だからコロナ初期からノーマスクだけど案外絡まれないものよ
ひとり旅が趣味だけどノーマスク旅も解放感があって良いものよ
したい人はすれば?よく苦しくないわねって感じ+37
-8
-
171. 匿名 2022/10/03(月) 22:06:02
別に外す弊害もあんまりないしなぁ
お互いの顔だって、食事とか水分補給の時にわかるし+7
-6
-
172. 匿名 2022/10/03(月) 22:06:17
サッカーでも声出ししてるじゃん+4
-0
-
173. 匿名 2022/10/03(月) 22:06:24
>>94
私も冬は毎日、夏もずっと付けていたかったけど、夏にマスクしてると「風邪?」って聞かれるのが面倒くさくてはずしてたな。懐かしい笑+7
-1
-
174. 匿名 2022/10/03(月) 22:06:27
>>160
まーでもあの頃はマスクの効果過信されてたし
今はもうマスクしててもしてなくても感染者数の変動に影響ないってわかってきたわけで+46
-3
-
175. 匿名 2022/10/03(月) 22:06:30
>>149
ネカマの臭いがする+7
-1
-
176. 匿名 2022/10/03(月) 22:06:37
街を見渡すとマスクマスクでゾンビ映画見てるみたいよ
マスクしてないゾンビ外は私だけーみたいな+58
-7
-
177. 匿名 2022/10/03(月) 22:06:55
今日学校の運動会のお知らせきた。
マスク着用してくださいって書いてあった。
話すならマスクしてからにしてくださいってしてほしい。
私はボッチだから誰とも話さない。+27
-0
-
178. 匿名 2022/10/03(月) 22:06:57
>>18
わかる。カーッペッ!ってのが路上でしてる人、マスク時はそんな見かけなかったんだよなー。+74
-4
-
179. 匿名 2022/10/03(月) 22:07:01
スーパーでマスクしてる老人
野菜とかナイロン袋に入れる時に
マスクずらして指を舐めるのだけは
やめてくれ+16
-0
-
180. 匿名 2022/10/03(月) 22:07:02
>>135
あと専門家の方の意見を参考にもできる+17
-1
-
181. 匿名 2022/10/03(月) 22:07:02
>>144
マスクしてる人がノーマスクに殴られて死んだ+9
-2
-
182. 匿名 2022/10/03(月) 22:07:17
本当にマスク外させる気があるなら、厚労省が濃厚接触はもう家庭内と病院と高齢者施設に限るっていうのをもっとはっきり言えばいいと思う。
全数把握がなくなって、実質濃厚接触の特定なんてもう不可能なんだし。
濃厚接触対策のマスクやめるだけでも少しは変わると思う。+47
-0
-
183. 匿名 2022/10/03(月) 22:07:26
>>150
いや、一緒に歩いてた友達もマスクしてたし本当に周りみんなマスクしてて。
だから私がおかしいやつ扱いされて見られてるのかなと思った…信号待ちの時チラチラって見てくる人もいたし+24
-8
-
184. 匿名 2022/10/03(月) 22:07:33
これ屋内もマスク外してOKってハッキリ
政府がいわないから外マスク減らないんだよ
いまだにどの店もマスクしないと入れないじゃん
店でマスクして外出てマスク外してって
いちいちめんどいんだよ
だからつけてる人って多いと思う
あと駅構内とかもマスク外しOKって
政府はいえよ!
じゃなきゃいつまでたっても
マスクマン終わらないぞ?
+122
-5
-
185. 匿名 2022/10/03(月) 22:07:36
>>21
スーパーで着けるなら外でも着けちゃうんだよね
つけたり外したり面倒だから+90
-4
-
186. 匿名 2022/10/03(月) 22:07:41
>>171
え?
仕事先全員で食事すんの?
それとも小さい会社?+0
-3
-
187. 匿名 2022/10/03(月) 22:07:42
>>7
スーパーはしてほしいな
いくらぼっちで買い物きてて誰とも話さなくても
くしゃみとかされたらイヤじゃん
オッサンとか平気でつばとか飛ばしそう+424
-140
-
188. 匿名 2022/10/03(月) 22:07:55
マスクまじで息苦しい+24
-1
-
189. 匿名 2022/10/03(月) 22:08:07
>>177
こんなことしてるからコロナ終わらないんだよね+42
-1
-
190. 匿名 2022/10/03(月) 22:08:28
マスクより消毒がもういらないと思う。
本当に消毒できてるかどうか怪しいし、ベタベタするやつとか臭いやつとかに当たると本当気持ち悪い。
帰ったら手を洗えばいいだけ。+48
-5
-
191. 匿名 2022/10/03(月) 22:08:37
>>187
防護服おすすめ+55
-19
-
192. 匿名 2022/10/03(月) 22:08:37
ちゃうねん‥外で外してても屋内入ってマスクして、また外して、またつけて‥ってしてたら化粧もドロドロになってくるし最後はそれ見られたくなくて隠すためと、めんどくさくなるからつけっぱなしになるねん‥
つけたり外したりするの億劫で出かけることも億劫なってきてるねん
肌弱いから吹出物とか荒れまくりでそれも辛いねん+40
-3
-
193. 匿名 2022/10/03(月) 22:08:49
>>183
ちなみに追記なんだけど地方都市だとノーマスクは視線感じるんだけど
この前東京行った時は全然感じなかった
田舎と都会の違いもあるなって思ったよ+44
-3
-
194. 匿名 2022/10/03(月) 22:08:54
>>10
散歩とかゴミ捨てはマスクしないで行くよ。+96
-2
-
195. 匿名 2022/10/03(月) 22:09:04
>>67
スーパーとかお店では入口に「マスク着用」とか書いてるから着けてるわ。でもあの張り紙もう要らないと思う+48
-20
-
196. 匿名 2022/10/03(月) 22:09:19
>>192
確かに化粧崩れるもんな
だから私は逆にマスク着けないで外出するわ
+9
-1
-
197. 匿名 2022/10/03(月) 22:09:26
外したい。コロナのせいで新婚旅行も行けてないし。マスク外して新婚旅行いきたーい!+20
-3
-
198. 匿名 2022/10/03(月) 22:09:40
>>67
でも、コンビニとかは入店時はマスク着用の貼り紙してない?+34
-13
-
199. 匿名 2022/10/03(月) 22:09:51
>>9
私はコロナもインフルもただの風邪も罹りたくないからこれからの時期マスクは外せない+134
-16
-
200. 匿名 2022/10/03(月) 22:09:57
>>170
私も去年から屋外では普通にノーマスクだったわ
去年の夏とか狂気だったよ、気温34度の炎天下で私以外の全員がマスクしているんだからね
+19
-0
-
201. 匿名 2022/10/03(月) 22:10:01
>>160
450億円のマスク+4
-2
-
202. 匿名 2022/10/03(月) 22:10:08
>>184
それ!お年寄りとかテレビ見てる人多いんだし岸田さんが会見してきちんと言えばいいだけじゃんね。+43
-1
-
203. 匿名 2022/10/03(月) 22:10:17
屋内でもマスクは必要ないですよ![岸田首相「マスク、屋外不要」を強調 メッセージの出し方に苦悩]()
+83
-0
-
204. 匿名 2022/10/03(月) 22:10:33
>>195
逐一店の張り紙って見る?
ある日小さく感染予防のためにゴーグルもしてくださいって書いてあったら次の日からするん?+16
-10
-
205. 匿名 2022/10/03(月) 22:10:39
狭い歩道でノーマスク二人組が喋りながらこっち向かってきてすれ違うのきつかった
道路で工事してたから逸れることもできない+8
-23
-
206. 匿名 2022/10/03(月) 22:10:44
屋外でも屋内でもマスク外しを強く推奨って言えばいいのに
それでもその他の理由とかでしたい人はすればいい
保険かけたような言い方してるからいつまで経っても気味悪いマスク集団が終わらないんだよ+75
-2
-
207. 匿名 2022/10/03(月) 22:10:54
>>90
幼稚園外で会ったときは大概ノーマスクなので、そのまま素顔で喋ります!
けど、送迎の時だけは忖度しちゃう。
情けない。+34
-1
-
208. 匿名 2022/10/03(月) 22:10:56
>>2
検討おじさん+116
-2
-
209. 匿名 2022/10/03(月) 22:10:58
>>187
コロナ禍終わっても一人でしてて下さい。+61
-42
-
210. 匿名 2022/10/03(月) 22:11:23
いつもマスクちゃんとして消毒も徹底してる人があっさり感染したしな
私はそんなに注意してないけどまだ感染してないわ
もう変わんなくね?
空気感染説あるし、もう運だよ+46
-2
-
211. 匿名 2022/10/03(月) 22:11:40
>>197
この間旅行したけど綺麗な若いカップルがノーマスクで楽しそうに歩いてたよ
ノーマスクで行けばいいやん
新婚時代は今だけやで?+65
-3
-
212. 匿名 2022/10/03(月) 22:11:41
>>186
超大きいけど部署人数が少ないところ
社食でも見られるじゃん+3
-2
-
213. 匿名 2022/10/03(月) 22:11:52
なんでいきなり全部外させそうとするのかも意味わからん
だから終わんないんだよ!ってウイルスなんだからつきあっていくしかないじゃん
折り合いつけるための過渡期でしょ?+9
-15
-
214. 匿名 2022/10/03(月) 22:12:06
>>13
なんでおかしいの?
大っぴらに顔隠して歩ける犯罪者は喜ぶだろうけど+54
-4
-
215. 匿名 2022/10/03(月) 22:12:19
>>16
本当だよね〜。体調に不安がある人、体調を崩さないようにしたい人はつけるでいいんじゃないのかな。+127
-4
-
216. 匿名 2022/10/03(月) 22:12:24
マスクから基準値を超えるホルムアルデヒドが検出される
ホルムアルデヒドは発癌性のある有害物質
厚生労働省 国立医薬品食品衛生研究所より![岸田首相「マスク、屋外不要」を強調 メッセージの出し方に苦悩]()
+33
-2
-
217. 匿名 2022/10/03(月) 22:12:24
>>176
都下住みだけど、屋外は1割くらいはノーマスになってきた感じ。
良い感じに増えてる。+10
-2
-
218. 匿名 2022/10/03(月) 22:12:32
>>205
ガスマスクお勧め+19
-3
-
219. 匿名 2022/10/03(月) 22:12:42
>>199
そういう人いるけど、もう無菌室で生きるしかないと思うわ+22
-25
-
220. 匿名 2022/10/03(月) 22:12:51
>>1
屋内も会話する時も原則外させろ+46
-6
-
221. 匿名 2022/10/03(月) 22:13:14
なんかここめちゃくちゃ反マスク湧いてない?+10
-27
-
222. 匿名 2022/10/03(月) 22:13:15
>>18
吐くやつはマスクしてても吐くよ。+95
-0
-
223. 匿名 2022/10/03(月) 22:13:18
>>21
そんなごった返しになってるわけでもないお店で、陽性者がマスクなしでひとりで無言で買い物してるときに、他のお客さんにどうやって感染させるの?空気感染ってこと?
くしゃみも、真正面からハクションってやられでもしなければ、うつるとは思わないんだけどなぁ。+45
-36
-
224. 匿名 2022/10/03(月) 22:13:25
まぁマスクをしてれば、100パー感染させないし、しない!って事ならともかく、これだけ感染者も出てるし、マスクで完全に感染を防ぐ事は無理なんだから、そもそも強要するのがおかしいよ。
それに家の中では結局マスク外しちゃってるんだし、ほぼ意味ないよね。
体調悪い人、風邪気味な人、基礎疾患持ちの高齢者など感染したら命に関わる可能性がある人以外は、屋外屋内問わずマスクは自由にしたら良いと思うけど?
屋内でも必要なのは、病院や高齢者施設ぐらいでは?+31
-0
-
225. 匿名 2022/10/03(月) 22:13:48
田舎だから車乗るほうが多いしもちろん車運転するときはマスクなんてしないけど、たまにマスクして運転してる人見るわ。もう癖になってるとしか思えない。+8
-1
-
226. 匿名 2022/10/03(月) 22:14:03
>>184
ちょっとずつ小出しにしていくのほんま鬱陶しいわ
自分は海外では着けてないくせにw+64
-0
-
227. 匿名 2022/10/03(月) 22:14:14
>>9
紫外線対策にもなるしね!+14
-13
-
228. 匿名 2022/10/03(月) 22:14:14
>>218
花粉の時期これしてるけど威力絶大だわ
コロナ気にする人はガスマスクすればいいのにっていつも思ってる![岸田首相「マスク、屋外不要」を強調 メッセージの出し方に苦悩]()
+20
-0
-
229. 匿名 2022/10/03(月) 22:14:33
>>213
外人が旅行に来るからマスクしなくて良いですよって言いたいが為
でも国内で感染が増えた場合に叩かれるのが嫌だから屋内ではマスク推奨
いつも通り外人に媚びて国民を踏み付けてるだけのこと+46
-0
-
230. 匿名 2022/10/03(月) 22:14:37
コロナはただの風邪じゃないので、マスクはするよ
+5
-8
-
231. 匿名 2022/10/03(月) 22:14:50
>>9
インフル予防から花粉症の流れで着けるな
取るのは来年の梅雨前だわ^^;+77
-7
-
232. 匿名 2022/10/03(月) 22:14:53
>>10
私も外せない
感染するの怖いし
皆、よく外せるなって思う+6
-45
-
233. 匿名 2022/10/03(月) 22:14:53
>>18
歩きタバコも増えそう+31
-2
-
234. 匿名 2022/10/03(月) 22:15:06
>>221
さすがに反マスクにもなるやろ
健康な人のマスクに科学的根拠ないやん
強いて言えば喉の保湿になることくらいやろ+29
-5
-
235. 匿名 2022/10/03(月) 22:15:15
>>225
外すの面倒なだけだろうけどね
でも業者さんとか仕事中の人はクレーム入るから外せないとか+3
-0
-
236. 匿名 2022/10/03(月) 22:15:18
>>228
呼吸は楽なの?+2
-0
-
237. 匿名 2022/10/03(月) 22:15:21
>>204
ゴーグルてw持ってねーわ!
でもどうしてもその店じゃなきゃ買えない何かがあるとかならゴーグルするかもね。ドレスコードみたいなもんじゃない?+4
-5
-
238. 匿名 2022/10/03(月) 22:15:24
ノーベル賞受賞オットー・ワールブルグ
「細胞に供給する酸素を35%減少させて、48時間経てば発癌する」
マスク含有発癌物質+マスクによる低酸素で発癌率上昇
![岸田首相「マスク、屋外不要」を強調 メッセージの出し方に苦悩]()
+24
-3
-
239. 匿名 2022/10/03(月) 22:15:35
マスクつけてるじゃん+2
-0
-
240. 匿名 2022/10/03(月) 22:15:45
>>187
ネットスーパーで買えば?+32
-16
-
241. 匿名 2022/10/03(月) 22:16:08
>>212
え?社食で見れるがよくわからないな
今の時期に食堂で密昼食?
それに人数多いなら社食じゃない人、デスク昼飯、外食も相当数いるはずだよね?
部署内だけに限定して顔見れるとかいってんならズレてるかと+1
-2
-
242. 匿名 2022/10/03(月) 22:16:11
>>228
ええやん、コロナ怖い人は全員これしたら着けてない人も気にならんやろ+24
-0
-
243. 匿名 2022/10/03(月) 22:16:12
エレベーターでマスクなしの人が乗ってたから乗りたくなかったのにその人どうぞって入らせようとしてきた
何も考えてないんだろうな+5
-18
-
244. 匿名 2022/10/03(月) 22:16:20
>>21
屋内ではまだまだつけてほしいよね
外したいと言う人が多くてビックリする+39
-71
-
245. 匿名 2022/10/03(月) 22:16:23
ダイソーの30枚100円の白が売り切れてた
早く入荷して欲しい+2
-5
-
246. 匿名 2022/10/03(月) 22:16:35
>>10
自律神経やられてから本当に息苦しいので外では外してるよ
じゃないと倒れそうになる⋯
店内でも外したいのが本音だけど周りの人は嫌だろうし、自分自身も変な目で見られるのが嫌だから我慢してる+94
-1
-
247. 匿名 2022/10/03(月) 22:17:02
>>200
こっちからしたら優越感感じるよね
我慢乙ですって感じ+6
-1
-
248. 匿名 2022/10/03(月) 22:17:05
>>111
屋内は密閉してるからダメ
屋外とは違うんだよ
辞めてほしい+13
-51
-
249. 匿名 2022/10/03(月) 22:17:19
>>219
そういうことじゃない
反マスクの人って本当に思考が極端だよね+35
-16
-
250. 匿名 2022/10/03(月) 22:17:19
>>221
私の認識では
反マスク=全員マスクを取れ!つけてるヤツは成敗だ!
脱マスク=マスクはしてもしなくてもいいよね、個人の自由
私自身は脱マスク派のつもり
+23
-1
-
251. 匿名 2022/10/03(月) 22:17:20
マスクは雑菌の温床![岸田首相「マスク、屋外不要」を強調 メッセージの出し方に苦悩]()
+40
-1
-
252. 匿名 2022/10/03(月) 22:17:21
>>21
こういう「○○は××だからまだしててほしい」みたいな人ってよく見るけど、その基準もそれぞれ違うから揉めてると思うわ
屋外だろうが屋内だろうがしたい人はする、したくない人はしないで良いと思うんだけどね
コロナ前はそれが自然だったんだしさ+140
-14
-
253. 匿名 2022/10/03(月) 22:17:26
さっさと5類にしろよ。
まさか来年まで引っ張る気?
もううんざりなんだけど。2020年入学の中高生は3年間コロナで終了しちゃうよ?
屋外はマスク外すなんて当たり前だし。何なら2020年からそうしてたわ。もう屋内でもいらないわ。
あとアクリル板検温消毒もアホらしいから全部撤廃してよ。+106
-2
-
254. 匿名 2022/10/03(月) 22:17:35
水際緩和されてノーマスクの外国人観光客いっぱい入ってきたらその人達に対する対応はどうすんの?と思う
日本人はおとなしい人多いから日本人には従わせて、外国人だけ特別扱いとかふざけたことしないよね?
と思うけど、この際他力本願だろうが子供達のために外国人観光客によってノーマスク広がればいいのにとも思ってしまう+47
-1
-
255. 匿名 2022/10/03(月) 22:17:45
>>243
あ、大丈夫ですぅって階段使うのお勧め
運動にもなるし+8
-0
-
256. 匿名 2022/10/03(月) 22:17:47
観光客だって、そりゃ聞かれれば「ない方がいいです」って言うだろうけど、大した負担でもないし文句言わなくない?
マスクだけで観光に来ないとかありえないし、見るべきなのは別のところな気がするんだが+6
-8
-
257. 匿名 2022/10/03(月) 22:18:05
>>62
○○ちゃんのママって、いつもマスクしてないね、って周囲の大人にも子供にも思われてそう
同じ幼稚園だったら私もなんとなく話しかけづらいかな+13
-29
-
258. 匿名 2022/10/03(月) 22:18:19
>>208
遣唐使じゃなくて
検討使だね+25
-0
-
259. 匿名 2022/10/03(月) 22:18:21
>>157
ウイルスも弱毒化してるし怖くない。
マスクしてても感染するし感染させる。ワクチンも一緒。
怖いと言ってたら何も出来ないし、家にこもってろとしか言えない。+54
-4
-
260. 匿名 2022/10/03(月) 22:19:06
これから冬に向かってインフルもあるしマスクは外せない+3
-5
-
261. 匿名 2022/10/03(月) 22:20:15
>>253
アクリル板も検温もアホらしいよねw
形式だけで、まともに感染対策だと思ってやってる人どんだけいるんだろ+65
-0
-
262. 匿名 2022/10/03(月) 22:20:31
>>217
こちらは地元の高校生たちは外してるけど(外してるだけてわみんなかわいくてかっこよく見える)小学生の子供ゾンビだらけだわ
可哀想な犠牲者
大人は好きにせい+10
-1
-
263. 匿名 2022/10/03(月) 22:20:41
>>68
コロナが流行り出した頃から思ってるけど、陽性者も食品触ってるだろうし、レジでも媒介しまくりだと思う。
マスクの意味は。
あと、なっても死なないよ。+97
-28
-
264. 匿名 2022/10/03(月) 22:20:43
世界バレーの観客、マスクしてなかった。珍しく日本人もしてなかった。+23
-0
-
265. 匿名 2022/10/03(月) 22:20:50
マスクは咳などの症状がある人が着けるものであって
健常者が着けても意味はないし、逆にデメリットだらけ+21
-0
-
266. 匿名 2022/10/03(月) 22:20:51
この2年、大学に行けなかった。大学時代の思い出もゼロ。友達もゼロ。1学年下はもっと可哀想。高校生も修学旅行や文化祭なしだよね。この2年で何を得て何を失ったんだろう+49
-0
-
267. 匿名 2022/10/03(月) 22:20:59
>>176
そう!
この間2週間くらい海外にいて、帰って来たらまるでハリウッドのポストアポカリプス映画のように思えた
この島だけ放射能汚染かなんかで空気が悪くなってマスクしないと歩けないような
ドラえもんの映画でアニマルプラネットってあったじゃん?あれのニムゲの星のような
+19
-1
-
268. 匿名 2022/10/03(月) 22:21:12
>>221
ガルって反マスク派多い
マスクしてたいって人にお前一人でずっとしてろとか精神異常とか不細工だから外せないのかとか言うタチ悪い人もいる+15
-27
-
269. 匿名 2022/10/03(月) 22:21:36
コロナあんまり気にしてなくて、2回も陽性者とノーマスクで飲み食いして感染してない人がいる
一方で、めっちゃ気をつけてた人が2度も感染
もうわかんないよね+41
-0
-
270. 匿名 2022/10/03(月) 22:21:53
>>261
アクリル板はまだわかるけどピッて測れるやつは低く出るし意味ないよね+14
-0
-
271. 匿名 2022/10/03(月) 22:22:17
ごめん!こんなメッセージを出すことにすら苦悩するなら一国のリーダー失格だと思う。素質なし。
さよなら👋🏻+18
-0
-
272. 匿名 2022/10/03(月) 22:22:24
>>221
何故いちいちレッテル貼りするの?
3年目になれば誰だってマスクうんざりだよ。デメリットも大きいし。
逆にこれ以上マスク生活長引かせたい人の目的って何なの?+54
-8
-
273. 匿名 2022/10/03(月) 22:22:27
>>49
旅行割りとかイベント割り、もしかしていつか税金として国民に跳ね返らないのかな?経済回す意味でもワクチン接種の有無とわず平等にして欲しい。打った特典みたいになってるじゃない、感染リスクは変わらず症状の悪化を押さえるはずのワクチンなのに、まるで打てばかからないかのような安心材料扱い、打たなきゃ損みたいなの変だよね。+63
-1
-
274. 匿名 2022/10/03(月) 22:22:35
>>266
もう海外行けるから憂さ晴らしに行ってくれば?(円安だけれど)
そのくらいしないと悔いが残るよね
+11
-0
-
275. 匿名 2022/10/03(月) 22:23:33
>>118
世間はもう関心ないと思うよ、そこまで気にしてないでしょ
NHKのニュースでもあまり取り上げなくなったし+4
-0
-
276. 匿名 2022/10/03(月) 22:23:34
屋内でも不要でしょ
国民もアホな政府の指示待ちするな!
いい加減、自分の頭で考えて行動しろ!!+49
-2
-
277. 匿名 2022/10/03(月) 22:23:35
>>270
私逆に39.9度出たことあるよw
「今日暑いですもんね。冷房のあるところで体冷やしてからまた来てください」って言われてそうした
35.5度だった+16
-1
-
278. 匿名 2022/10/03(月) 22:23:43
>>7
汚ねーだろ
商品に他人の飛沫つくのも嫌だし+250
-84
-
279. 匿名 2022/10/03(月) 22:24:11
>>1
手始めに文科省にしつこいくらい言ってさ
学校の屋外マスク禁止を徹底させたほうがいいよ
未だに登下校マスク、運動会でテントにいる時もマスクの所がある
何のために拍手で応援しましょう、私語はやめましょうと呼びかけてるんだか
子供が可哀想すぎるよ
距離云々言うからこんなことになってるんだよ
大人は適当に外せるからさ、子供を何とかしてやってくれ
+91
-5
-
280. 匿名 2022/10/03(月) 22:24:23
>>261
知り合いの店主に聞いたら、やる必要がないって解ってるけれど、やってないと「なんでやらないんだ」って怒る客がたまーにいるから続けてるんだって
つくづく日本らしいというかなんというか
+32
-1
-
281. 匿名 2022/10/03(月) 22:24:31
>>7
公共の場かつ屋内はまだまだした方がいいと思うけどなぁ。
空気感染するといってもマスクで飛散するウィルス、吸い込むウィルスの量を減らすことはできるから、免疫の仕組みを考えても曝露量を少なくするのは重症化回避に大事なこと。
ちなみにアメリカ在住だけどスーパーや公共交通機関では半分以上マスクしてる。
外ではみんなしてない。
なんか寒くなってきてマスクする人また増えてきた印象。+65
-62
-
282. 匿名 2022/10/03(月) 22:24:42
>>268
マスク信者も「外してるのはブスばかり」だとか罵倒してたよねー+14
-4
-
283. 匿名 2022/10/03(月) 22:25:01
>>10
ほとんど人がいない裏道なら外せるけど、駅前のような人がまあまあ多いところは迷う。どんな考えの人が混じっているか分からないから。+9
-15
-
284. 匿名 2022/10/03(月) 22:25:10
すでにとっくにマスクしてない。
ほんと日本てマスクキチガイだよな〜
+58
-1
-
285. 匿名 2022/10/03(月) 22:25:38
>>280
あとなんか、感染対策やってましたーってことであれやっとかないと補助金出ないとか+8
-0
-
286. 匿名 2022/10/03(月) 22:25:46
>>177
子供の園の運動会を体育館でやったのですが、親も子も不織布マスク強制でした。
競技中の子供のマスクは先生が一括管理するって言うからどうするんだろうと思ったら、洗濯ばさみで挟んで洗濯物みたいに干されてましたw
ほぼしゃべらない待機中はマスクして競技の時は外すんですが、競技中は大きい声で掛け声とか叫ぶみたいな場面がたくさんありました。
どう考えてもマスクが感染対策にはなってないと思いました。+34
-0
-
287. 匿名 2022/10/03(月) 22:25:46
>>67
変えるのは政府だよ
+1
-15
-
288. 匿名 2022/10/03(月) 22:25:53
>>196
それができるのがいちばんやんな。。
会社行くとマスク必須やから事務職とはいえ1日過ごしたらドロドロやねん…
それが恥ずかしくてもう最後は隠すためにつけてるねん。だから蒸れて顔がもう皮膚炎みたいになってもたりしてて辛いで+16
-0
-
289. 匿名 2022/10/03(月) 22:25:58
>>16
結局室内でつけるなら屋外だけ外すのが面倒くさいから皆屋外でもマスクしてるんだよね。「屋内室内どちらも不要。つけたい人だけ継続」って宣言すれば、外す人沢山出てくる。+173
-3
-
290. 匿名 2022/10/03(月) 22:25:59
>>67
何と戦ってんの?
真実に気づいちゃってる系?+17
-30
-
291. 匿名 2022/10/03(月) 22:26:02
>>264
今問題になってるインドネシアのサッカーの客もマスクしてないし、大声で応援どころか乱闘してたからねw
東南アジアもマスク規制終わるの遅かったけれど変わってきた
+13
-0
-
292. 匿名 2022/10/03(月) 22:26:57
>>155
自己紹介かな+49
-41
-
293. 匿名 2022/10/03(月) 22:27:02
>>248
こう言う人が居るからコロナが終わらない+59
-10
-
294. 匿名 2022/10/03(月) 22:27:18
>>280
とりあえず声のでかい人に従っておくっていうね・・・
多数派という数で勝ってる方が正しくてノーマスクは変人っていう風潮も悪いよね+11
-0
-
295. 匿名 2022/10/03(月) 22:27:41
>>278
コロナ前はどうやって生活してたの?
スーパーはおろか、パン屋、飲食店とか全部むきだしだったけど+64
-10
-
296. 匿名 2022/10/03(月) 22:27:48
>>100
>>マスクしてブサイク隠したところでブサイクなのはかわらない
ワロタ うまい事言うね+20
-1
-
297. 匿名 2022/10/03(月) 22:27:52
>>22
今年の猛暑ですら外してない人いたから夏もずっとつけてると思う…+49
-5
-
298. 匿名 2022/10/03(月) 22:27:55
結局やっぱり、高齢者と肥満の人が重症化するらしいね
これで結論は出てる
高齢者と肥満の人だけマスクすれば?+12
-0
-
299. 匿名 2022/10/03(月) 22:28:05
5類へ変更はどうしちゃったの
それをしないとマスクも外れないし、スポーツ観戦で声も出せないし、子ども達の黙食も終らない+38
-0
-
300. 匿名 2022/10/03(月) 22:28:13
>>68
インフルエンザは毎年その状態だったんだから問題ないよ。+54
-9
-
301. 匿名 2022/10/03(月) 22:28:15
岸田さん…やろうと思えば24時間いつでもメッセージ発信できるよ?一体何を躊躇してるの??苦悩するレベルが低過ぎるでお話にならないわ。こんな些細なこともできないで政治家?総理大臣?呆れる😂😂+51
-0
-
302. 匿名 2022/10/03(月) 22:28:24
>>193
だってノーマスクに注意して下半身麻痺にされた人もいたじゃん
やべえ奴と関わりたくないから皆んな無視してるんだよ+29
-13
-
303. 匿名 2022/10/03(月) 22:28:30
いやああああああ!!!!!!!!!!!!!!!!!!!!
駄目だよ!!!!!!!!!!!!!!!!!!
マスクは義務!!!!!!!!!!!!!!!!!!
国民の義務!!!!!!!!!!!!!!!!!!
憲法改正して国民の義務にすべき!!!!!!!!!!!!!!!!!!
まだコロナが終わってないんだよ!!!!!!!!!!!!!!!!!!
感染爆発が悪化したらどうするの!!!!!!!!!!!!!!!!!!
嫌だ嫌だ嫌だ嫌だ嫌だ嫌だ嫌だ嫌だ嫌だ嫌だ!!!!!!!!!!!!!!!!!!
私は絶対に感染したくない!!!!!!!!!!!!!!!!!!
+1
-19
-
304. 匿名 2022/10/03(月) 22:28:40
室内でも不要でいいて
マスクを持っていくってこと自体がめんどくさい+43
-1
-
305. 匿名 2022/10/03(月) 22:28:49
飲食店のアクリル板とかコンビニのレジ前の飛沫防止ビニールはもう撤去して欲しい。あれ絶対ついてる方がはるかに汚い。+50
-1
-
306. 匿名 2022/10/03(月) 22:28:55
>>7
義務じゃないから、マスクしないで買い物してる人増えてきてるよ。
いい傾向だ。+76
-99
-
307. 匿名 2022/10/03(月) 22:29:01
二類な限り無理では?
今って純粋にコロナが怖い人ってどれくらい居るんだろう。
周りから変な目で見られるからマスクをする。コロナに罹ると周りに迷惑をかけるからコロナになりたくない。クラスターが問題になるのが怖いからイベント制限をかける。
なんかコロナより周りを恐れてる人の方が多い気がする。
+47
-0
-
308. 匿名 2022/10/03(月) 22:29:21
>>244
意味ないんだから+35
-10
-
309. 匿名 2022/10/03(月) 22:29:29
マスクするストレスと免疫力低下で感染者増えたんじゃない?未だに騒ぐのも良くない。病は気から、いつまでも心配ばかりしてるとろくなことにならない。+18
-0
-
310. 匿名 2022/10/03(月) 22:29:48
>>2
お前は文句ばっかだけどねw+6
-19
-
311. 匿名 2022/10/03(月) 22:30:03
>>13
顔が不自由な人はたいへんだな~+54
-9
-
312. 匿名 2022/10/03(月) 22:30:13
>>193
わかる!都内に住んでて実家が仙台なんだけど、久々に帰省したら外でも着用率ほぼ100パーセントで驚いたw
普段は駅構内とかホームはノーマスクなのになんだか外すの躊躇したもん+26
-0
-
313. 匿名 2022/10/03(月) 22:30:34
外したい人は外す!したい人はご自由に!
それでいいじゃん。
コロナとマスクのことで日本嫌いになりそう。ばかばかしくなってきたから、最近ははずすようにしてる。
外で1人で歩いてるのにマスクしてるの意味わからない。いまは花粉症の時期だし,これから寒くなるからしたい人もいるのは分かる。でも、それ以外の人、せめて1人でいるときは外しましょうよ。
こんなに周りの目を気にする国に生きてるんだと思うと息苦しい。変えたい。+64
-4
-
314. 匿名 2022/10/03(月) 22:30:37
>>21
こういう人外食しないの?屋内でマスク外して食事してるけど大丈夫なん?+111
-13
-
315. 匿名 2022/10/03(月) 22:30:45
もうさどこでもマスク自由でいいでしょ。みんなよく頑張ったよ。とりあえず岸田は無能。+59
-0
-
316. 匿名 2022/10/03(月) 22:30:50
>>276
そうしたいけど職場は自分の判断ではないし、プライベートもからまれたりしそうだったり、やはりちゃんと国として決めて欲しいとは思う+10
-0
-
317. 匿名 2022/10/03(月) 22:30:54
花粉飛んでるし喘息だし…マスクに慣れてしまった。冬は外せないけど、来年の春にはコロナ落ち着いてるかな?そうしたらはずしたいな。
+1
-1
-
318. 匿名 2022/10/03(月) 22:30:56
>>307
最初から全然怖くない。+14
-1
-
319. 匿名 2022/10/03(月) 22:31:14
>>286
うわぁ
狂気を感じる+15
-1
-
320. 匿名 2022/10/03(月) 22:31:17
>>17
え、おじさんの気持ちわかる。
+37
-8
-
321. 匿名 2022/10/03(月) 22:31:23
>>1
1人で外を歩く際にも着けているのはやりすぎだ。
これは完全同意+70
-3
-
322. 匿名 2022/10/03(月) 22:31:33
いまだに一度も感染してない人って実は無症状感染者なのかな?
田舎じゃなくて人の多いところに住んでて+1
-2
-
323. 匿名 2022/10/03(月) 22:31:47
>>9
毛糸のマスクでもつけとけ+9
-21
-
324. 匿名 2022/10/03(月) 22:31:57
顔全面出すのもう無理なった。
外したい人は外せばいい+6
-8
-
325. 匿名 2022/10/03(月) 22:31:59
>>21
顔つき合わせて大声で話す訳でもないんだからもういいよ。気になる人はマスクしてたら+14
-6
-
326. 匿名 2022/10/03(月) 22:32:01
このままマスクつけ続けるとほうれい線が深くなるだけ
外させてもらうわ、あんま長い、もういいでしょ+36
-1
-
327. 匿名 2022/10/03(月) 22:32:06
ニンニクたっぷりのラーメン食べた後にマスクしたら、いつまでもラーメン臭だった。+1
-2
-
328. 匿名 2022/10/03(月) 22:32:33
>>286
日本らしい非生産さ+11
-2
-
329. 匿名 2022/10/03(月) 22:33:12
>>1
岸田に影響力ないやろ、良くも悪くも国内外に影響力ない総理っていうのも珍しい+7
-1
-
330. 匿名 2022/10/03(月) 22:33:13
真面目な国民も滑稽だけど、まずは岸田が毅然としたメッセージを発すれば良いだけやん。悩む意味が解らん。また増えた時に責任取らされるのが怖い?他何もしないんだからそれくらいはしたら?+35
-1
-
331. 匿名 2022/10/03(月) 22:33:21
ワクチン接種廃止も早く
何人犠牲になったと思っているのよ
いい加減にしろ!+24
-1
-
332. 匿名 2022/10/03(月) 22:33:31
でもさー街歩いててリモートワークできる
ボックス部屋?みたいなテナントができてるの見かけた
あれ見た時 人と人との距離を置かせる行為と
まだコロナ終わらせる気ないのかなって感じた+3
-1
-
333. 匿名 2022/10/03(月) 22:33:35
マスク外したら季節の金木犀の匂い、すごく気持ち良くリフレッシュ。3年間もマスクしっぱなしなんて心身に悪いわ。+44
-1
-
334. 匿名 2022/10/03(月) 22:33:41
>>278
マスクの隙間からもウイルスうようよ出てきて商品に付着しまくってるよ+40
-7
-
335. 匿名 2022/10/03(月) 22:33:55
>>277
死んでる笑+4
-1
-
336. 匿名 2022/10/03(月) 22:34:06
>>326
やっぱりほうれい線深くなる?
どういうメカニズムでなのかな
私確実にそうなったけど、単なる老化なのかなとも
だってもう3年だもん・・・+7
-2
-
337. 匿名 2022/10/03(月) 22:34:06
>>312
仙台の着用率エグいよね(笑)
わたしもこの前行ったら外してる人全然いなくて驚愕した+16
-1
-
338. 匿名 2022/10/03(月) 22:34:11
マスクしてないだけで、おばあさんや子供が殴られた事件があった
こういう社会を作ってるのはマスク信者や
同調圧力に屈してマスクし続けてる民衆なんだよ
政府の言いなりになってないで、自分たちで自由を勝ち取りに行かなきゃ+30
-2
-
339. 匿名 2022/10/03(月) 22:34:28
>>72
ついでに岸田も
+36
-5
-
340. 匿名 2022/10/03(月) 22:34:44
高齢者や障害者施設では外せるのかな?子供が早く外したがってるんだけど。+5
-1
-
341. 匿名 2022/10/03(月) 22:34:59
マスコミと政府が一体になってマスクしてない人は反社会的勢力のようなレッテル貼りしたから、相当宣伝しないとマスクは外れないよ。
現に小学生高学年~高校生くらいの女子にはマスクは洋服のようなもんになっちゃったから+31
-1
-
342. 匿名 2022/10/03(月) 22:34:59
>>21
1人黙って買い物してるなら問題ないでしょ。
陽性者はマスクしたあなたかもしれないし。+38
-13
-
343. 匿名 2022/10/03(月) 22:35:26
>>320
そのおっさんもまさかノーマスクでマスクしろって言ったりしてね。+4
-3
-
344. 匿名 2022/10/03(月) 22:35:27
>>4
私はガソリン入れる時は着けてないな+40
-5
-
345. 匿名 2022/10/03(月) 22:35:29
>>313
同感。
昨日歩いてコンビニに向うときにうっかりマスクしてたからすぐ外した。外では着けないように意識してる。+12
-1
-
346. 匿名 2022/10/03(月) 22:35:39
>>11
今さらって、
夏前からずっとから言われてましたよ。+23
-1
-
347. 匿名 2022/10/03(月) 22:35:52
>>78
個人的にはマスク生活が精神的にすごく楽です
視線恐怖症みたいなとこあったから
人の目を気にせず出歩けるのが本当にストレスフリーです+12
-28
-
348. 匿名 2022/10/03(月) 22:36:13
>>2
検討は記憶にあるけど
検討した結果が記憶に残らない+137
-2
-
349. 匿名 2022/10/03(月) 22:36:27
どんどんと緩和されてるな。
3年近くかかったけど結局スペイン風邪と同じコースか。+8
-0
-
350. 匿名 2022/10/03(月) 22:36:29
>>133
東京郊外だけど、自転車で移動する時は顎マスク
サイクリングやランニングしてる人はノーマスクの人が多い
まあまあ人いるから遠慮しちゃうとこもあるけど、地方こそ外して良さそうなのに+47
-0
-
351. 匿名 2022/10/03(月) 22:37:04
>>322
そうじゃない?
私は大阪だけど周りもみんな無症状でかかってたんだろねーって言ってる+2
-0
-
352. 匿名 2022/10/03(月) 22:37:18
徒歩出勤の時はノーマスクでも職場に入った途端に着けなきゃいけないから、結局マスクは1枚使うのかー。ケチくさくてスマン。+17
-0
-
353. 匿名 2022/10/03(月) 22:37:21
>>244
マスクについて勉強してほしい+36
-10
-
354. 匿名 2022/10/03(月) 22:37:22
>>295
パンやお惣菜が個包装になったの最高じゃん
目覚めた側の人達は以前のままが平気みたいで羨ましいわ+40
-12
-
355. 匿名 2022/10/03(月) 22:37:27
>>251
ガーセスクなんて恐ろしいよねw+0
-2
-
356. 匿名 2022/10/03(月) 22:38:11
首相の演説は「屋外で外す」ことの浸透を狙ったものだが、「近くで会話をしない限り」と「留保付き」の表現となった。
え?結局今までと言ってること変わらなくない?
てか「近くで会話しない限り」←これあるなら結局子どもたち外せなくないか?うちの地域の小学校、全員登下校マスクしてるし。+52
-0
-
357. 匿名 2022/10/03(月) 22:38:18
>>290
横だけど誰かが外さないとマスク圧力が強まって子供にまで着けさせて発達に影響出るでしょ
茶化すのやめてほしい+60
-4
-
358. 匿名 2022/10/03(月) 22:38:19
>>78
日が落ちてからだと人が沢山いる駅周辺でも外してる人グンと増えるのよ
暗くて顔見られないと外すハードル下がるんだろうね
+68
-2
-
359. 匿名 2022/10/03(月) 22:38:22
>>21
感染多いのは家庭内だよ。
家族と家にいるとき、絶対マスクしててくださいよ。+60
-10
-
360. 匿名 2022/10/03(月) 22:38:33
>>72
ちなみにインフルエンザウイルスも外国から来るのよ+23
-0
-
361. 匿名 2022/10/03(月) 22:38:44
>>248
マスクしてたら密閉なの?息が出来ないじゃんw+23
-2
-
362. 匿名 2022/10/03(月) 22:38:59
>>276
指示待ちせず堂々とした結果バスや飛行機降ろされるんだから責任逃れせず政府がきちんと指示するべき。+9
-1
-
363. 匿名 2022/10/03(月) 22:39:01
どっちの立場からでも「あいつら聞く耳持たない」+1
-1
-
364. 匿名 2022/10/03(月) 22:39:05
ホテルだっけ?マスクしてなかったら入館拒否できるみたいな法律できたよね?何がしたいの?+19
-1
-
365. 匿名 2022/10/03(月) 22:39:09
>>303
怖いです+1
-0
-
366. 匿名 2022/10/03(月) 22:39:16
岸田も加藤も外国ではマスクしないやん、、、
空気読んで外してるならもうマスクしてることは感染対策にはならない。+29
-0
-
367. 匿名 2022/10/03(月) 22:39:17
>>336
マスク外した瞬間に、水分まで奪われて乾燥するらしい、あと、表情筋を使わないからたるむ。おじさんは関係ないかもだけど女性には割と死活問題+14
-0
-
368. 匿名 2022/10/03(月) 22:39:26
岸田もう後が短いからかやりたい放題ね
自身の長男を秘書官だって
岸田文雄氏長男が首相秘書官に 「人事活性化と連携強化のため」(毎日新聞) - Yahoo!ニュースnews.yahoo.co.jp岸田文雄首相は4日に自身の長男で公設秘書の翔太郎氏を首相秘書官とする人事を発令する方針を固めた。政府関係者が明らかにした。理由については「首相官邸内の人事の活性化と岸田事務所との連携強化のためだ」
岸田文雄首相は4日に自身の長男で公設秘書の翔太郎氏を首相秘書官とする人事を発令する方針を固めた。政府関係者が明らかにした。理由については「首相官邸内の人事の活性化と岸田事務所との連携強化のためだ」と説明している。+21
-0
-
369. 匿名 2022/10/03(月) 22:39:37
>>321
思考停止の馬鹿なんだと思う。+30
-3
-
370. 匿名 2022/10/03(月) 22:39:44
>>23
厚労省幹部って書いてあるじゃん。引用してるのに、分からないの?
相変わらず、政府と官僚の違いもわからないのね。与党と野党の違いくらいはわかるよねー?+4
-10
-
371. 匿名 2022/10/03(月) 22:39:54
>>71
むしろ布マスクかメッシュマスクしか使っていないんだが。
マスクなしだとジムに入館できないのよ。+15
-0
-
372. 匿名 2022/10/03(月) 22:39:54
>>244
あなたにビックリする+41
-10
-
373. 匿名 2022/10/03(月) 22:39:57
>>21
人によって基準がマチマチなのは仕方ないと思うけど、いつまでもそんなこと言ってるのもどうなのかなぁ?と思ってしまう。
むせてる程度じゃなくひどく咳き込んでるならマスクしててほしいけど、それより一人一人が免疫高めておくように心掛けることも大事かなと。+35
-4
-
374. 匿名 2022/10/03(月) 22:40:14
>>356
こんなことコロナ初期から厚生労働省が言ってた
へんな条件着けるから外でもはずせないんだよ+31
-0
-
375. 匿名 2022/10/03(月) 22:40:24
>>100
まぁ不細工というか陰キャが多く感じる。
夏のリア充で溢れかえている江ノ島はマスク率低かったし、お水の仕事という可能性もあるが夜の歌舞伎町の美人は殆どノーマスクだった+24
-1
-
376. 匿名 2022/10/03(月) 22:40:34
>>244
だって意味がないから
いつまでこんな意味のないくだらないことを強制され続けるのだ?客の善意?と懐につけ込むのもいい加減にしろと言いたい。もう2年半だよ?+47
-8
-
377. 匿名 2022/10/03(月) 22:40:37
>>2
外交に関しては、勝手に即決する癖にね。+93
-1
-
378. 匿名 2022/10/03(月) 22:40:43
>>1
マジ無能総理+11
-1
-
379. 匿名 2022/10/03(月) 22:40:47
>>4
普通に考えたら確かに周りに人があまりいない方がマスク警察に絡まれるリスクも少なそうで外しやすいけど、逆にマスク警察に絡まれた場合のことを考えると人気のない場所で絡まれる方が怖いかもね
マスク警察とか店員とのトラブルがやっぱり怖いって人多そうな気がする+8
-2
-
380. 匿名 2022/10/03(月) 22:40:47
>>356
阿呆だね。
近くかそうじゃないかいちいちジャッジが面倒だから一律マスクになっちゃってるのに何がしたいんだ?この人?+4
-1
-
381. 匿名 2022/10/03(月) 22:41:17
>>13
こちらも助かります。+9
-3
-
382. 匿名 2022/10/03(月) 22:41:24
>>71
マスクになんてもうびた一文たりとも払いたくない
+27
-0
-
383. 匿名 2022/10/03(月) 22:41:38
>>326
私は下唇の下に深い横線のシワが出来てしまったよ。マスクの位置がきになって、下唇で変に動かしてへの字口になっていたから香○照之の顎そっくりになってしまった。アラフィフだからシワは仕方ないのかな?マスク取るのが怖いw+4
-0
-
384. 匿名 2022/10/03(月) 22:41:54
>>66
ズボラなんですね+6
-5
-
385. 匿名 2022/10/03(月) 22:41:59
>>358
確かに夜飲み歩くときはノーマスク率高いわ
顔見られたくないだけだったんだね😇+21
-0
-
386. 匿名 2022/10/03(月) 22:42:21
屋内でも必要ないですよね?岸田さん![岸田首相「マスク、屋外不要」を強調 メッセージの出し方に苦悩]()
+29
-0
-
387. 匿名 2022/10/03(月) 22:42:44
ここまでじゃないけど、元々冬はマスク必須だったからしばらくはするな+2
-3
-
388. 匿名 2022/10/03(月) 22:42:48
>>5
外の記者会見でマスク外して話せばいいのに。+132
-0
-
389. 匿名 2022/10/03(月) 22:43:10
>>195
春くらいからずっとノーマスクです。
マスクお願いだけなら全然入る。
でもマスク未着用入店禁止だったら入らない。+21
-1
-
390. 匿名 2022/10/03(月) 22:43:17
>>7
咳エチケットしない人いるから嫌だ
咳エチケットするならいいけど+159
-23
-
391. 匿名 2022/10/03(月) 22:43:22
>>5
発言してる場所は室内だからじゃない笑+53
-5
-
392. 匿名 2022/10/03(月) 22:43:39
>>207
私はもう送迎の時も一人でノーマスクだけど保護者会とか保育参観のときはプリントにマスク着用って書いてあるから仕方なくつけていってる。さすがにルールとして書かれてたら無視できないし…個人の自由にしてほしいんだけどな。+34
-3
-
393. 匿名 2022/10/03(月) 22:43:40
>>314
飲食店でマスク外しておしゃべり飲食しておきながら「飲食店店員はずっとマスクしててほしい(><)」とか言い出す+90
-3
-
394. 匿名 2022/10/03(月) 22:43:49
>>305
めっっちゃ汚い。
店員さんの声聞こえなくて思わず、え!?って顔近づけたら一瞬あの汚いシートが顔に触れて本当に凹んだ。+16
-1
-
395. 匿名 2022/10/03(月) 22:44:17
もう俺は自転車乗る時マスク外すから軽蔑の眼差しで見るなよ+1
-1
-
396. 匿名 2022/10/03(月) 22:44:22
>>293
マスク外す人がいるからコロナが終わらない
このプラスを見ても分かるように、ノーマスクに反対してる人も多いんだよ
だからまだマスクは必須+6
-41
-
397. 匿名 2022/10/03(月) 22:44:23
表参道行ったらやっぱ綺麗な子はマスクしてなかった
コンプある子はずっと外せないと思う+15
-2
-
398. 匿名 2022/10/03(月) 22:44:24
日本あるある![岸田首相「マスク、屋外不要」を強調 メッセージの出し方に苦悩]()
+26
-0
-
399. 匿名 2022/10/03(月) 22:45:04
早くマスクなしの生活に戻りたい。+28
-0
-
400. 匿名 2022/10/03(月) 22:45:16
日本がマスクがここまで定着したのって
風邪ひいたら他人に移さないためにマスクするっていう昔からの習慣があったからでしょ?
全く習慣がなくて政府が呼びかけても聞かない国と比較するのは違うよ+1
-10
-
401. 匿名 2022/10/03(月) 22:45:27
>>21
ノーマスク反対派が沢山いることを知ってほしい
まだまだマスクはするべき+6
-40
-
402. 匿名 2022/10/03(月) 22:45:30
>>13
怖い、ノイローゼ気味じゃね?+57
-4
-
403. 匿名 2022/10/03(月) 22:45:30
>>374
ここはマスコミ得意の切り取り報道で
屋外マスク不要ってめちゃくちゃ報道してほしい。+6
-0
-
404. 匿名 2022/10/03(月) 22:46:00
>>401
嫌だす。+15
-0
-
405. 匿名 2022/10/03(月) 22:46:24
>>244
まぁがんばれ![岸田首相「マスク、屋外不要」を強調 メッセージの出し方に苦悩]()
+49
-10
-
406. 匿名 2022/10/03(月) 22:46:45
>>290
事実やん
このままだとダラダラとずっとマスクつける流れが続く+29
-1
-
407. 匿名 2022/10/03(月) 22:46:50
>>30
これほどマスクが風邪予防になるって知らなかったよ+16
-17
-
408. 匿名 2022/10/03(月) 22:47:06
>>338
あとマスコミの煽りも加担してる
岸田はとにかく子供のことを第一に考えて発言ほしい+25
-0
-
409. 匿名 2022/10/03(月) 22:47:09
>>390
それ!
両手があいててもフェックショーーン!と豪快にくしゃみする人もいるし
+16
-4
-
410. 匿名 2022/10/03(月) 22:47:11
んー
リアルな話屋外はほぼノーマスク、電車内とか密なところは不織布マスクかな
回りに合わせるとかじゃなくて自分の判断ね+7
-2
-
411. 匿名 2022/10/03(月) 22:47:18
>>4
外で人がいようが会話もしないから外す。
マスクの意味が無い事ぐらい
いちいち総理に言われなくても
コロナ禍の始めから分かりきっている。+103
-11
-
412. 匿名 2022/10/03(月) 22:47:36
>>314
しないよ
コロナ禍になってからしたことない
外食してる人を見てびっくりするわ
飲食店も閉めるべきだといつも思ってる
これじゃ収まらないよ+12
-39
-
413. 匿名 2022/10/03(月) 22:47:38
>>68
コロナかどうかでなく「コンコンする人」がマスクつけるのがマナーなのでは?
無症状ならコロナ陽性だろうがノーマスクでかまわんわ+110
-6
-
414. 匿名 2022/10/03(月) 22:47:41
幼稚園の送迎でマスク外すのが恥ずかしい
皆同じみたいでまど誰も外してない
普通は誰も見てないと思うんだけど絶対噂話のネタにする性悪なママいるからな…
この前の運動会なんて先生も園児も外してるのに保護者は全員マスクでシュールだったよ+5
-2
-
415. 匿名 2022/10/03(月) 22:47:50
>>400
風邪症状ある人も外せなんて言ってないけど。
今マスクしてる人みんな体調悪いのかな?違うと思う。+6
-0
-
416. 匿名 2022/10/03(月) 22:48:09
コロナがゼロになるまでずっとマスクさせるつもりかな。子供が小1のときにコロナが始まって今3年生だけど、6年生までマスクだったら。。って考えると恐ろしいわ。+20
-0
-
417. 匿名 2022/10/03(月) 22:48:20
>>2
遣唐使ならぬ・・・検討使+25
-1
-
418. 匿名 2022/10/03(月) 22:48:24
か、花粉症の私はオールシーズンつけます。
今は稲刈りの時期でつらい。+0
-3
-
419. 匿名 2022/10/03(月) 22:48:27
>>6
ほんともったいない
誰だよ不織布じゃないと意味ないとか言った奴〜+140
-1
-
420. 匿名 2022/10/03(月) 22:48:28
>>257
相手も話しかけてこなくて大丈夫って感じだと思いますよ。
それでも仲の良い友達は気にせず話しかけてくるだろうし。
それより子供達を本来の姿に戻してあげないと。
マスク依存症になってしまうよ。+28
-0
-
421. 匿名 2022/10/03(月) 22:48:28
>>396
逆。マスクを外さないからコロナが終わらないんだよ
いつまでたっても集団免疫がつかない+55
-4
-
422. 匿名 2022/10/03(月) 22:48:33
>>11
マスク=感染、ではない。いつになったら学ぶんだろう。+26
-2
-
423. 匿名 2022/10/03(月) 22:48:47
てか何で国会で言うの?ちゃんと記者会見して発信した方がインパクトあると思うけど+12
-0
-
424. 匿名 2022/10/03(月) 22:48:57
>>371
ほんと、それでいいですよね。
洗うの面倒というのもあるけど、つい不織布をつけてしまう己の弱さよ…+2
-0
-
425. 匿名 2022/10/03(月) 22:49:07
学校も?そんなこと言うとうちの子はマッハで外しますよ。+0
-0
-
426. 匿名 2022/10/03(月) 22:49:26
>>417
つ 座布団+2
-0
-
427. 匿名 2022/10/03(月) 22:49:29
>>401
えっと、いつまででしょうか?w
コロナがおさまることなんて多分一生ないのだけど。
増えては減っての繰り返し+30
-1
-
428. 匿名 2022/10/03(月) 22:49:47
>>396
ほぼマスク着けてる今の状況で終わってないじゃん。
もう結論出てるんだよ。マスクしても感染拡大防止は無理ですと。そもそもマスクのパッケージに感染を完全に防ぐものじゃないと書いてる。
気休め程度の対策が最重要対策になってて滑稽もいいところ。+51
-3
-
429. 匿名 2022/10/03(月) 22:50:00
>>140
私スーパー、コンビニもマスクしてないです。
ずっと黙ってるし、セルフレジだし。+55
-19
-
430. 匿名 2022/10/03(月) 22:50:22
>>210
だよねー。
うちは夫が外仕事のため仕事中ノーマスク、昼食は職場の人たちと食べて飲み会も週一くらいであるけど一度も感染してない。
私は在宅ワークで外出は買い物くらい、家でもマスクしてたけど感染した。
この前ノーマスクで3泊の旅行に行ったけど感染しなかった。もう運。マスクしてたら確率下がるとも思えない。+9
-3
-
431. 匿名 2022/10/03(月) 22:50:26
>>15
もし屋内でも半分以上の国民が自主的にマスク外し出したら国とか店がどんな対応するのか気になるね+62
-1
-
432. 匿名 2022/10/03(月) 22:50:29
>>416
大人が外していかないと子供達が外せるわけない。
私は自分の子供達にはマスクしなくて良いと伝えてます。
もちろん私もどこへ行くのもノーマスク。+30
-0
-
433. 匿名 2022/10/03(月) 22:50:35
>>21
スーパーに陽性者?笑
未だにコロナコロナ言うなら自分が二重マスク、ゴーグルでもしてれば良いじゃん。めんどくせー+100
-31
-
434. 匿名 2022/10/03(月) 22:51:10
>>25
どうぞ。私は外すし、外してるけど。。+31
-4
-
435. 匿名 2022/10/03(月) 22:51:31
>>408
大人のことも考えて欲しい。
私、大人だけどマスク心の底から無理。
イライラする。+22
-0
-
436. 匿名 2022/10/03(月) 22:51:34
>>376
結果論だけどこの3年は無駄なことばかりありましたねー+22
-2
-
437. 匿名 2022/10/03(月) 22:51:43
それより、減税してよ。+9
-0
-
438. 匿名 2022/10/03(月) 22:51:47
>>401
反対派が沢山いることなんて知ったこっちゃないわ
強制じゃないんだし+17
-1
-
439. 匿名 2022/10/03(月) 22:51:56
>>25
誰かに外せと頼まれてるんか?+5
-1
-
440. 匿名 2022/10/03(月) 22:51:59
>>90
顔ひっつけてしゃべるわけじゃなし、くだらないと思いつつも、仲良いママさんがマスクをわりと信じてる人だから仕方なくつけている感じ。
幼稚園園内も空気的に逆らえない。+25
-2
-
441. 匿名 2022/10/03(月) 22:52:51
>>435
大人は適宜外せばよい
私はコロナ初期から自己判断で着けていない+1
-1
-
442. 匿名 2022/10/03(月) 22:52:53
>>34
2メートルだろうが、1メートルだろうが、すれ違うだけで感染するような恐ろしい病なら、とっくに全滅してるよ。+60
-0
-
443. 匿名 2022/10/03(月) 22:52:54
電車の中とか人が多いところはマスクしてるけど
外歩いてる時は顎マスクしてる+1
-0
-
444. 匿名 2022/10/03(月) 22:53:09
マスクしない人は今でもしないし、移りたくない人はマスクすればいいし。今までも何回かCMでも周知してなかったっけ??
私は時と場合で付けたり外したりしてる。
+7
-0
-
445. 匿名 2022/10/03(月) 22:53:18
>>350
地方はまだまだマスク信仰根深いよ…会社なんかもう取れる日がくるとは思えない…まあ今年の春に今更マスク強制にされた自分はしれっとマスクやめましょうなんて言われたら悪いけど一発かましてやりたくなる。+8
-0
-
446. 匿名 2022/10/03(月) 22:53:33
>>396
マスク着用率トップの日本が感染者数世界一になってたのによく言うわ。説得力無し!!!+42
-2
-
447. 匿名 2022/10/03(月) 22:54:07
「付けなくていい」でいいのになんで「外すのを徹底」なんだ…どっちかに振り切らないといけない理由あるの?コロナ流行る前から夏は日焼け対策、冬は防寒で付けてたのに今後は「まだコロナ気にしてる」とか言われるんだろうか。+8
-0
-
448. 匿名 2022/10/03(月) 22:54:18
>>418
花粉症だからつけます
ってコメントもういいよ。
文脈的にマスク必要としてない人もマスク強要されるのが嫌だって話でしょ。
花粉症でもなんでも必要ならつけてればいいって。
論点ずれてるよ。+12
-0
-
449. 匿名 2022/10/03(月) 22:54:27
>>244
外したくない人にびっくりするわ。+40
-10
-
450. 匿名 2022/10/03(月) 22:54:29
>>1
経済、戦争、コロナ、国民が自民党に殺される+18
-1
-
451. 匿名 2022/10/03(月) 22:54:45
>>401
『自分は付ける』でいいんじゃないの?みんな外せとか言ってるわけではないし。+25
-0
-
452. 匿名 2022/10/03(月) 22:54:49
>>13
心の病だと思うが、実際こういう人増えてそう
ガルちゃん見てても思うけど、コロナ以降清潔であることが絶対正義みたいな思考に陥ってる人よく見るわ
人間なんてもともと不潔なものよ+72
-0
-
453. 匿名 2022/10/03(月) 22:54:58
>>10
え?はずせよ
私は外している+58
-1
-
454. 匿名 2022/10/03(月) 22:55:41
>>21
ネットスーパー使えば?+16
-7
-
455. 匿名 2022/10/03(月) 22:56:03
>>412
人生つまんな+29
-3
-
456. 匿名 2022/10/03(月) 22:56:14
>>412
率直な疑問だけど、何が楽しくて生きてるの?なにか楽しみあればいいんだけど…+12
-3
-
457. 匿名 2022/10/03(月) 22:56:29
>>305
だいぶ前だけどスーパー勤務の妹にあれって掃除してるの?と聞いたら案の定そんなもんしてないよと言われたw+19
-0
-
458. 匿名 2022/10/03(月) 22:56:38
そもそも自然免疫なんて獲得してないよ。感染者の何割かは再感染だと思う。ワクチンだって良いのか悪いのか微妙なラインだし。+6
-0
-
459. 匿名 2022/10/03(月) 22:57:18
>>21
心配な人はネットスーパー使えばいいじゃん
いくらマスクしても人と接する限り感染するんだからさ
+35
-14
-
460. 匿名 2022/10/03(月) 22:57:26
>>55
その日本製の不織布マスクからもホルムアルデヒドが検出されるという皮肉。日本製だからといって安全なわけではない。添加物・農薬大国であるように、日本の基準は驚くほどゆるい。+58
-2
-
461. 匿名 2022/10/03(月) 22:57:30
>>78
人目を気にしてるんじゃなくて
ツバがめちゃくちゃ飛ぶことを学習してしまい
バッチイからつけてる感がある+6
-21
-
462. 匿名 2022/10/03(月) 22:57:35
マスコミが一斉に新型コロナのこと一切報じなくなれば自然とマスクやめる人増えてくる
+8
-0
-
463. 匿名 2022/10/03(月) 22:57:39
>>412
コロナ収束させるためなら飲食店経営者が○んでも構わない感じ?+8
-6
-
464. 匿名 2022/10/03(月) 22:58:36
>>401
知ったとしても、こっちは従わない。うるさい。+15
-0
-
465. 匿名 2022/10/03(月) 22:58:52
>>3
大半が無意味だと分かっているのに、誰かに言われないと外せない国民。まるで幼稚園。+179
-20
-
466. 匿名 2022/10/03(月) 22:59:12
こんな当たり前の事発表する程でも時間かけて検討する事でもない
他にやる事ないんか?
あんた一年何してた?+3
-0
-
467. 匿名 2022/10/03(月) 22:59:24
お前はもっとやるべきことあるだろ、、、+3
-0
-
468. 匿名 2022/10/03(月) 22:59:26
>>357
フォローありがとうございます😊+4
-1
-
469. 匿名 2022/10/03(月) 22:59:37
>>18
指舐めはコロナ禍でもマスクずらしてずっとやってまーす。
ほんと気持ち悪いあんなに殺意のわく瞬間ない。+102
-2
-
470. 匿名 2022/10/03(月) 22:59:41
マスクを着けるもはずすも自分の考えでする。政府が何と言おうと関係ない。+5
-0
-
471. 匿名 2022/10/03(月) 23:00:02
>>401
強要罪+9
-0
-
472. 匿名 2022/10/03(月) 23:00:02
>>67
マスクしてない人がいたら避けて通る+30
-40
-
473. 匿名 2022/10/03(月) 23:00:20
>>290
いやマスクしてる人もウイルスと戦ってるようだけどことごとく負けてるやんw+20
-1
-
474. 匿名 2022/10/03(月) 23:00:23
>>432
学校はマスク外してる子もいるし、私ももういいんじゃないかと思うのですが、学童がマスク必須で。布じゃなくて不織布にしてくださいってお手紙までわざわざ配布がありました。しかも昨日。+21
-0
-
475. 匿名 2022/10/03(月) 23:00:31
>>16
どこにおいてもここの判断にしてください
の言葉だけでいい気がする。
これ聞いて、室内はダメなんだね。よし、みんなで監視するぞってなるのはわかりきったこと。+22
-0
-
476. 匿名 2022/10/03(月) 23:00:39
公園とか人がすくない場所なら、すでにみんなマスク外してる人が多いが
駅周辺とか人が混雑してるとこで外すと、凄い目で見てくると人がいる
屋外不要と総理も大臣も言ってるのに
韓国とか東南アジアも人混みでもマスクを普通に外してるし、プロテニスやF1とかの屋外のイベントでもマスクせずに歓声をあげてるのに、なんで日本だけこんなになってしまったのか
+14
-0
-
477. 匿名 2022/10/03(月) 23:01:10
>>13
好きにしてくれ+21
-0
-
478. 匿名 2022/10/03(月) 23:01:26
もう涼しくなるから屋外ならマスクでもいいや。+1
-1
-
479. 匿名 2022/10/03(月) 23:01:31
>>90
全然話す!
話したくなかったら向こうから来ないでしょ。
+7
-3
-
480. 匿名 2022/10/03(月) 23:01:33
>>236
不織布マスクの4倍楽+1
-0
-
481. 匿名 2022/10/03(月) 23:01:42
>>7
ジジイやおじさんは突然の爆音くしゃみするし、ババアと奥さん方は通路を塞ぐように立っておしゃべりしまくってるし、子供もノーマスクで謎の咳込みしょっちゅうしてるし奇声を上げて走り回ってるのに親は注意もしなけりゃ手も繋がない、学生は集団で来て迷惑なほど大騒ぎしてる。
コロナは終わったわけじゃないしスーパー薬局は特に体の弱い人も必ず来る場所で、そもそも騒ぐような遊び場じゃないのから屋内はまだ全員マスクでお願いしたい。+190
-78
-
482. 匿名 2022/10/03(月) 23:02:01
>>7
スーパーはコロナ抜きにしても一部の人にはマスクしてて欲しいな(笑)
よりによって惣菜の前で大きなくしゃみとか咳を手や腕で覆うこともしない人、本当にイヤだ。だいぶカバーするスーパーも増えたけど。
+154
-20
-
483. 匿名 2022/10/03(月) 23:02:12
>>461
守るのは口だけでいいの?
全身にツバがめちゃくちゃかかるのは気にならないんだね+8
-0
-
484. 匿名 2022/10/03(月) 23:02:28
>>472
もう少しウイルスについて学んだ方が良いかと。+24
-3
-
485. 匿名 2022/10/03(月) 23:02:46
>>481
そんなに日本人が汚いと思うなら、日本から出ていけよ+56
-27
-
486. 匿名 2022/10/03(月) 23:03:04
>>248
屋内って言うけど常に換気扇回してると思うのよ。
ウイルスが完全に無くなることなんかないんだから言い出したらキリがない+26
-3
-
487. 匿名 2022/10/03(月) 23:03:06
>>356
何を今さらなことをわざわざ会見で言う滑稽さ
サクッと指定感染症外します
ただの風邪でした、ごめんね位言えよ+20
-0
-
488. 匿名 2022/10/03(月) 23:03:27
>>10
こういう人ばかりだから子供も外せない+63
-0
-
489. 匿名 2022/10/03(月) 23:03:45
ニューヨークでは交通機関でもマスク義務撤廃
日本がどんどん世界から取り残されていく![岸田首相「マスク、屋外不要」を強調 メッセージの出し方に苦悩]()
+34
-1
-
490. 匿名 2022/10/03(月) 23:03:49
>>463
え、飲食店経営者の生活のために外食しないといけないの?
コロナになって何日間も学校や会社に行けないと困るから自分のために外食は極力しないようにしてる。+5
-8
-
491. 匿名 2022/10/03(月) 23:04:08
>>326
私は鼻のてっぺんに丸いシミが…。
きっとマスクによる摩擦が原因。
来月シミ取り予約取ります。+10
-0
-
492. 匿名 2022/10/03(月) 23:04:22
マスク大嫌い。。
都内通勤だけどマスク外してる。
おじさんの臭い匂いに耐えられない時のみしてる。+14
-0
-
493. 匿名 2022/10/03(月) 23:04:23
>>10
こういう人が一番理解できない、、自分で判断できない良い大人が多いと感じる。情けない。+93
-0
-
494. 匿名 2022/10/03(月) 23:04:37
>>472
してる人でも避けようよ+5
-1
-
495. 匿名 2022/10/03(月) 23:04:41
全面解禁してくれないと面倒だしつけたままよ+0
-1
-
496. 匿名 2022/10/03(月) 23:04:57
>>191
よーし
見てくる+4
-3
-
497. 匿名 2022/10/03(月) 23:05:20
>>209
おう!するぜ!!
当たり前やん+10
-9
-
498. 匿名 2022/10/03(月) 23:05:25
岸田がここまで言ったわけには、11日から入国大幅緩和が関係してるんだろう
このままじゃ、ノーマスク外国人をマスク脳が差別しまくるから+9
-0
-
499. 匿名 2022/10/03(月) 23:05:26
>>490
飲食店閉めろとか言ってるからでしょ
+10
-3
-
500. 匿名 2022/10/03(月) 23:05:29
>>13
サウジアラビアにでも移住しな。+29
-5
コメントを投稿する
トピック投稿後31日を過ぎると、コメント投稿ができなくなります。削除すべき不適切なコメントとして通報しますか?
いいえ
通報する

岸田文雄首相は3日の所信表明演説で、新型コロナウイルス対策でのマスク着用について「引き続き、屋外は原則不要だ」と強調した。海外で「ノーマスク」の国が増え、国内でも「いつになったら外せるのか」との声が強まっている。政府は、新型コロナと季節性インフルエンザの同時流行への警戒から、「ノーマスク」への完全移行は時期尚早とするが、国民の不満を和らげるためにも「屋外でのマスク外し」を徹底したい考えだ。